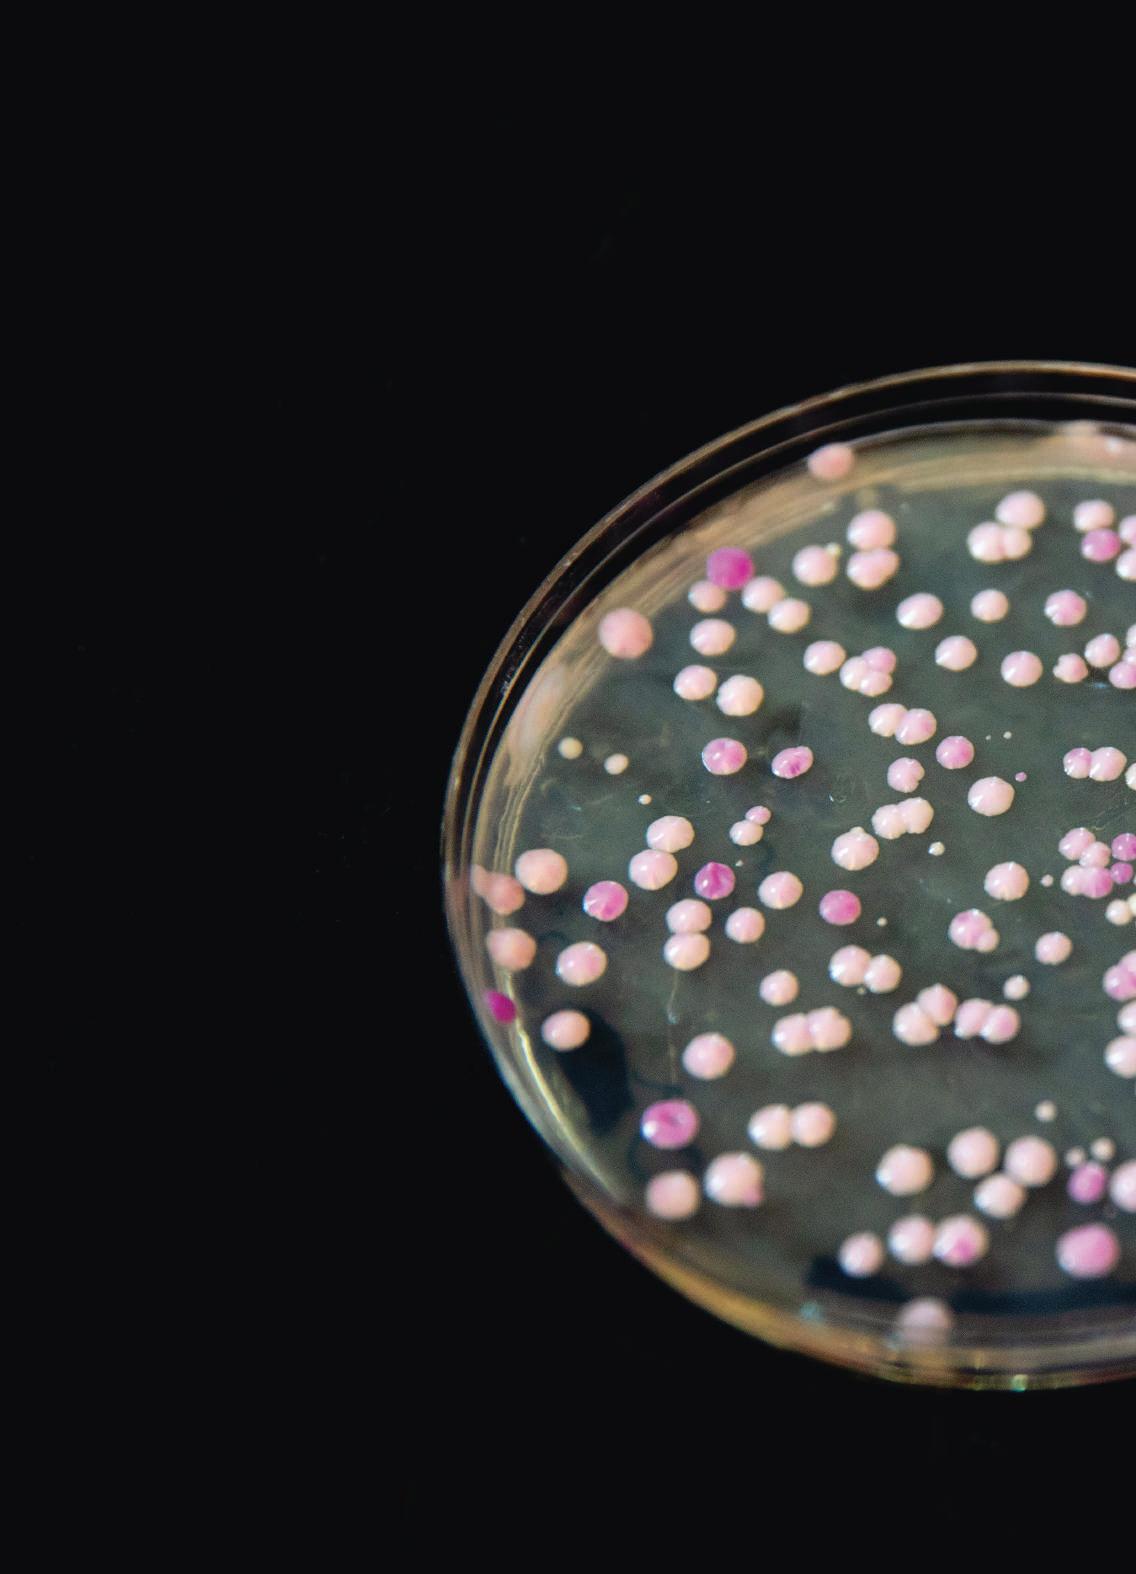

Health and Well-being


![]()



In a vibrant garden near USC’s University Park Campus, USC Dornsife environmental studies majors Munachiso “Muna” Obiefule (left) and Jack Chen bring classroom lessons to life. They are working with the Garden School Foundation, which uses the thriving, one-acre edible garden at 24th Street Elementary School to teach young students about healthy eating, urban gardening and environmental stewardship. This hands-on experience is part of a directed internship course from USC Dornsife’s Environmental Studies Program, part of the USC Wrigley Institute for Environment and Sustainability. “This is my dream job,” says Obiefule. “This internship has opened my eyes to fields I can go into after graduation.”

THE LONGEVITY GUIDE
Our experts share their research insights on how to live a longer, happier and healthier life.
BY SUSAN BELL AND MARGARET CRABLE
A TALE OF TWO CLIMATES
In a county divided by heat, USC Dornsife plants the seeds of change.
BY TOMAS WEBER
A NOVEL APPROACH
Narrative studies uses humanities tools to train medical students to be better listeners — and as a result better doctors.
BY MEREDITH MCGROARTY
“Adopting the right health behaviors is crucial for extending our years of good health.”
CLEARING THE CLOUDS
In the race to defeat dementia, scientists and psychologists are finding surprising clues to understand, prevent and treat the disease.
BY KATHARINE GAMMON
CRUNCHING CODE, CRAFTING CURES
How USC Dornsife is writing the formula for the future of medicine.
BY KATHARINE GAMMON
THE PAIN PARADOX
Our researchers are developing effective, new remedies to relieve pain without the risk of addiction.
BY MARGARET CRABLE

04 From the Dean Modern Medicine’s Unsung Heroes
05 Research Pulse The Beat of Breakthrough Science
06 Newsround USC Dornsife Scholars in the Media
54 Creative Writing Contest
Read the winning entry and discover the next theme
56 What if … We Could End Migraine Suffering?

08 In the Field Gene Craft
10 Healthy, Happy Trojans / Trash Therapies
11 Object Pedal Power
12 Take 5 Past Remedies
14 Snapshot Cancer Detective / The Detective’s Apprentice
16 Point / Counterpoint Is Technology Making Us More or Less Healthy?
With ingredients like licorice and salt, No-To-Bac might have provided a pleasant, temporary distraction from smoking but would not have cured the habit.

44 Alumni Insight: Kevin Huoh ’03 was inspired to become a pediatric surgeon by USC doctors who saved his life
48 Alumni News
51 In Memoriam: Jan Amend, divisional dean of life sciences and visionary scientist
52 Pathways: Randy Hetrick ’87 Tracing the unusual career path of the former U.S. Navy SEAL who invented TRX Suspension Trainers and became a successful entrepreneur p.12
“I want to share the hard, painful lessons I learned. If I can help folks coming up the ladder avoid those potholes and learn what I did but with less pain, then I’ll be happy.”
RANDY HETRICK ’87
FOUNDER AND CEO, OUTFIT TRAINING; FOUNDER AND CHAIRMAN, TRX TRAINING

EDITOR-IN-CHIEF
Susan Bell
CREATIVE DIRECTOR
Letty Avila
SENIOR ASSOCIATE DEAN FOR COMMUNICATION AND MARKETING
Jim Key
WRITERS AND EDITORS
Margaret Crable, Darrin S. Joy, Ileana Wachtel
DESIGN CONSULTANT
2communiqué
MULTIMEDIA NEWS DIRECTOR
Katie Kim Scott
VIDEOGRAPHER AND PHOTOGRAPHER
Mike Glier
SENIOR WEB SPECIALIST
Michael Liu
AUDIENCE ENGAGEMENT EDITOR
Christelle Snow
ADMINISTRATIVE ASSISTANT
Crisann Smith
CONTRIBUTORS
Jai Battle, Olga Burymska, Katharine Gammon, Stephen Koenig, Rachel B. Levin, Meredith McGroarty, Markos Mendez, Marcus Paulsen, Vanessa Roveto, Tomas Weber
DEAN, USC DORNSIFE
Amber D. Miller, Anna H. Bing Dean’s Chair
USC DORNSIFE BOARD OF COUNCILORS
Kathy Leventhal, Chair • Wendy Abrams, Robert D. Beyer, David Bohnett, Jon Brayshaw, Ramona Cappello, Alan Colowick, Richard S. Flores, Shane Foley, Vab Goel, Lisa Goldman, Jana Waring Greer, Pierre Habis, Yossie Hollander, Janice Bryant Howroyd, Martin Irani, Omar Jaffrey, Dan James, Bettina Kallins, Yoon Kim, Samuel King, Jaime Lee, Arthur Lev, Roger Lynch, Robert Osher, Gerald Papazian, Andrew Perlman, Lawrence Piro, Edoardo Ponti, Kelly Porter, Michael Reilly, Carole Shammas, Rajeev Tandon, Matthew Weir
USC DORNSIFE MAGAZINE
Published twice a year by USC Dornsife Office of Communication at the University of Southern California. © 2024 USC Dornsife College of Letters, Arts and Sciences. The diverse opinions expressed in USC Dornsife Magazine do not necessarily represent the views of the editors, USC Dornsife administration or USC. USC Dornsife Magazine welcomes comments from its readers to magazine@dornsife.usc.edu or USC Dornsife Magazine, SCT-2400, Los Angeles, CA 90089.
We have grown accustomed to headlines trumpeting medical breakthroughs — new drugs, new procedures, new ways to extend life and health. But we hear much less often about the foundational discoveries that made those advances possible. Biologists, chemists, physicists, neuroscientists and other experts invest years uncovering the foundational knowledge on which headline innovations are built. And the majority of these experts work at our nation’s research universities. The vaccines that helped the world mitigate the COVID-19 pandemic, for example, were developed with record-breaking speed only because academic researchers had been exploring the potential for mRNA to trigger a beneficial immune response for decades.

“Biologists, chemists, physicists, neuroscientists and other experts invest years uncovering the foundational knowledge on which headline innovations are built.”
Research universities play as critical a role today as ever in building the foundation for revolutionary discoveries, as breakthroughs increasingly result from the intersection of traditional fields and those that bring new perspectives. At USC Dornsife, our breadth of research and engagement across disciplines provides an ideal environment for incubating new ideas. Our natural science researchers are building the knowledge required to stop the progression of debilitating diseases and to eventually prevent them. At the same time, our social scientists and humanists are studying the environmental, cultural and economic factors that contribute to our health and well-being. We need to bring the full range of expertise to the table to effectively and comprehensively address human health issues.
As much as we share research breakthroughs and exciting discoveries, much of this work will always remain behind the scenes — often published in difficult-to-understand journals or books written for experts. This is part of the natural process, as foundational research is often done without a clear idea of which applications it will someday enable. It is driven by human curiosity and the desire to understand how things work. The headline breakthroughs that result years later in new technologies, less invasive treatments and new approaches taken by hospitals, companies and governments often come under someone else’s name. But the next time you read about an exciting breakthrough, try digging a little deeper. You just might discover that an unsung hero at your alma mater is the one who made it all possible.
RESEARCH COLLABORATIONS ACROSS ACADEMIC DISCIPLINES AND WITH EXTERNAL PARTNERS ARE MAKING SIGNIFICANT STRIDES IN THE ADVANCEMENT OF HEALTH AND WELL-BEING.
Imagine if breast cancer, which affects one in eight women, could be diagnosed from a few drops of blood. The ability to detect the disease more easily, cheaply — and accurately — than by using mammograms could save thousands of lives.
In one study, a new blood test developed by USC Dornsife physicist Peter Kuhn demonstrated 99% accuracy in detecting early-stage breast cancer. Kuhn plans to begin clinical trials of the test soon. Learn more on page 14.
The quest to slow or prevent the onset of Alzheimer’s disease and related dementias may hinge on uncovering their genetic markers. A $12 million National Institutes of Health (NIH) grant awarded to the USC Dornsife Center for Economic and Social Research (CESR) is fueling this pursuit. The funding enables CESR to genotype up to 20,000 participants in its expansive national survey panel.
Clinician burnout is threatening health care systems nationwide. The goal of a research collaboration between Public Exchange (PX), Keck Medicine of USC and others is to develop strategies to enhance the well-being of health care professionals and potentially revolutionize
support for medical providers throughout the country.
It’s a signature initiative of PX’s new Health and Wellbeing Practice.
Amid a demographic shift toward an older population, the role of caregivers is increasingly crucial, especially for family members and others who look after individuals with Alzheimer’s and related dementias.
With a $5 million NIH grant, CESR will harness wearable technology to monitor data related to the well-being of caregivers. This pioneering study could lead to strategies to significantly improve their quality of life.
USC Dornsife researchers are at the forefront of developing a promising strategy to make fentanyl, a powerful painkiller linked to many overdose deaths, safer for use.
In collaboration with researchers from other universities, their novel approach could reduce the drug’s addictive potential and side effects, offering hope for more effective pain management solutions. Learn more on page 40.
Public Exchange (PX) is USC Dornsife’s program to efficiently connect the right academic researchers with policy, industry and nonprofit partners to tackle some of the world’s most intractable issues.
1
2
During the COVID-19 pandemic, PX mobilized USC experts to analyze and improve food distribution strategies, significantly aiding Los Angeles County in addressing food insecurity effectively.
PX partnered with the City of L.A. to launch the Urban Trees Initiative, strategically increasing tree canopy in underserved areas to enhance community health and mitigate heat.
3
Last year, PX launched a dedicated health and well-being practice, directed by Sujeet Rao, a former senior policy advisor to the White House and veteran business leader.
“ We are the academic heart of USC, whose continued, steep ascent is due to our laser focus on having an impact that improves lives and communities today, tomorrow and into the future.”
AMBER D. MILLER DEAN, USC DORNSIFE
USC DORNSIFE SCHOLARS IN THE MEDIA

“It’s
like a time machine, giving us a glimpse of life during a period of profound change.”
DAVID BOTTJER (EARTH SCIENCES, BIOLOGICAL SCIENCES, ENVIRONMENTAL STUDIES) TO EARTH.COM REGARDING HIS RESEARCH INTO ONE OF EARTH’S MOST DEVASTATING MASS EXTINCTION EVENTS.
“Imagine a monster hurricane hits the mid-Atlantic seaboard on Election Day, shutting down D.C. and moving into Pennsylvania. Such an event could, very possibly, upend our democracy.”
JACOB SOLL (PHILOSOPHY, HISTORY, ACCOUNTING) TO POLITICO REGARDING THE POTENTIAL FOR POLITICAL CHAOS RESULTING FROM CLIMATE DISASTERS ON ELECTION DAY.
“I’M WRITING THE NOVEL THAT TWAIN WAS — NOT ILL-EQUIPPED — BUT UNEQUIPPED TO WRITE. THAT BEING THE STORY OF JIM.”
PERCIVAL EVERETT (ENGLISH) TO NPR REGARDING HIS NEW BOOK, JAMES, A RETELLING OF MARK TWAIN’S THE ADVENTURES OF HUCKLEBERRY FINN FROM THE POINT OF VIEW OF JIM, A CHARACTER WHO IS AN ESCAPED SLAVE.

“If you live in a Scandinavian country, you will be familiar with and may like this taste.”
EMILY LIMAN (NEUROSCIENCES, BIOLOGICAL SCIENCES) TO COSMOS REGARDING HER RESEARCH THAT SUGGESTS AMMONIUM CHLORIDE, THE KEY INGREDIENT IN SALTY LICORICE CANDY POPULAR IN SCANDINAVIA, MAY BE THE SIXTH BASIC TASTE.
“DESPITE THE REVERENCE WITH WHICH KING IS REMEMBERED, HE WAS ACTUALLY HIGHLY DIVISIVE DURING HIS LIFE.”
HAJAR YAZDIHA (SOCIOLOGY) IN AN ARTICLE SHE WROTE FOR TIME REGARDING MEDIA PORTRAYALS OF THE REV. MARTIN LUTHER KING JR. DURING HIS LIFETIME COMPARED WITH HOW HE IS PERCEIVED TODAY.

“ When Paris crowds seized the French king’s fortress in July 1789, they unwittingly created a model for every subsequent upheaval.”
NATHAN PERL-ROSENTHAL (HISTORY, SPATIAL SCIENCES, FRENCH AND ITALIAN, LAW) IN AN ESSAY HE WROTE FOR THE ATLANTIC REGARDING REVOLUTIONS.

“ There are things you can do that are much more climate impactful than recycling … It’s a lot easier to reduce your meat consumption than it is to do some of the other things we worry about.”
GALE SINATRA (PSYCHOLOGY, EDUCATION) TO THE ORANGE COUNTY REGISTER REGARDING “ECO-ANXIETY” AND WHAT PEOPLE CAN DO TO ADDRESS POLLUTION, WASTE AND CLIMATE CHANGE.
BY JIM KEY
In a major advancement in synthetic biology, a USC Dornsife research team led by Ian Ehrenreich, divisional dean for the life sciences, has developed a new method for creating synthetic chromosomes that could vastly improve human health and medicine.
The technique, known as CReATiNG (Cloning Reprogramming and Assembling Tiled Natural Genomic DNA), simplifies the process of chromosome construction, making it more cost-effective and accessible. It paves the way for significant medical advancements including the development of new pharmaceuticals, enhanced cancer therapies and more effective biofuels. Moreover, it holds promise for environmental cleanup efforts by creating organisms capable of breaking down pollutants.
Ehrenreich’s team has demonstrated that CReATiNG can also be used to manipulate the structures and contents of chromosomes in ways that could one day help humans adapt to life in space or other extreme environments, expanding the possibilities for long-duration space travel.
This breakthrough not only advances our fundamental understanding of genetic engineering but also opens new avenues for treating diseases and improving quality of life, showcasing the potential of synthetic biology to tackle some of the most pressing challenges in medicine and beyond.

Ian Ehrenreich, divisional dean for the life sciences and professor of biological sciences, explores the genetic factors that shape the wide array of observable characteristics in living organisms.

It’s the fourth week of his first semester on campus, and this student hasn’t made a single friend yet. Time to panic?
Not at all — just schedule a “Cat Chat” with USC’s director of belonging, Cat Moore ’05.
During these discussions, Moore, who has a degree in philosophy from USC Dornsife, guides students on how to make social connections. Once painfully shy, she gained her expertise through personal experience.
Cat Chats are just one of a variety of programs at USC Dornsife designed to help students improve their mental and physical well-being.
Over in the Department of Physical Education and Mind-Body Health, students can enroll in the recently launched mindbody studies minor. It offers a range of courses, from yoga and anatomy classes to Indian philosophy, to enhance students’ health and prepare them for medical careers.
Not all the healthy offerings are confined to campus. Students can also revitalize through Peaks and Professors, which organizes faculty-led hiking trips. (See inside back cover for more details.)
It’s a perfect way to recharge the batteries for another late-night study session in Leavey Library. —M.C.
The world now produces more than 350 million tons of plastic pollution every year. Unfortunately, less than 10% is recycled. The reasons are twofold: Most plastic waste doesn’t qualify for recycling, and even if it did, it’s still cheaper to produce new plastic than to recycle it.
Much of this plastic waste ends up in our natural environment, clogging our waterways and forming massive, floating islands of trash in our oceans.
Two USC Dornsife chemistry professors may have a solution: Travis Williams and Clay Wang have been turning plastic waste into pharmaceuticals and other valuable products.
Williams and Wang collected plastic trash from Avalon Harbor on Catalina Island, off the coast of Southern California, and broke down the materials into chemical groups called diacids. Next, they fed the diacids to engineered strains of Aspergillus nidulans, a fungus commonly used in drug development. Within a week, the fungus had produced significant quantities of antibiotics, antifungals, immunosuppressants and cholesteollowering statins.
This system also tackles polystyrene foam, which is particularly difficult to recycle and can release noxious chemicals into the environment. The chemists convert this foam into benzoic acid. Wang, chair of pharmacology and pharmaceutical sciences at the USC Alfred E. Mann School of Pharmacy and Pharmaceutical Sciences, then uses the acid to produce spores of the fungus Aspergillus flavus AF36. These spores are used for protecting corn corps by preventing aflatoxin poisoning, a dangerous conditon caused by toxic fungi that can lead to severe illness in humans and animals.
Williams and Wang’s research could revolutionize how we process plastic trash. “Clay and I are focused on how we can create the most beneficial uses from plastic waste so it has too much value to simply discard,” says Williams. —M.C.

DAVID HON ’72 IS THE INVENTOR OF THE DAHON FOLDING BIKE.
BY MARGARET CRABLE

“Being a peacenik at heart, I felt let down. So I switched course to do something good for the world.”
Before David Hon became known for his best-selling folding bikes, he made a quantum leap in nuclear fusion.
Born into a poor family in Hong Kong, Hon graduated from USC Dornsife in 1972 with a PhD in physics. He joined the Hughes Aircraft Research Lab in Santa Monica, California, where he developed an improved method to spark nuclear fusion with high-powered lasers — a technique still in use today. Despite its success, Hon struggled with the military applications of his work.
“Being a peacenik at heart, I felt let down,” he says. “So I switched course to do something good for the world.”
Hoping to reduce global car traffic pollution, Hon spent seven years
developing a better commuter bike in his garage. He debuted his folding bike in 1976 and six years later founded DAHON Inc. with his brother, Henry. Today, the company is the world’s leading seller of folding bikes, with most models on the road incorporating DAHON’s patented technology, according to Hon.
Bikes seem to be as good for individual health as they are for the planet. At 82, Hon continues to exemplify this, exercising daily and enjoying bike rides every weekend.

He says his invention is a living testament to the values he learned at USC Dornsife. “Think outside the box and think of humanity,” says Hon.
TAKE FIVE
BEFORE REGULATION OF MEDICINES
BEGAN IN THE EARLY 20TH CENTURY, QUACK REMEDIES PROLIFERATED. HERE WE TAKE A HUMOROUS LOOK AT SOME OF THE MOST STRIKING — AND FRANKLY BIZARRE — ADVERTISEMENTS USED TO PEDDLE THESE FRAUDULENT CONCOCTIONS. BY
MARCUS PAULSEN

RENNE’S MAGIC OIL Sometimes straightforward and to the point works best. This late 19th-century advertisement lets the reader know simply and quickly that this isn't just any snake oil, it’s magic snake oil — and it will take care of your pain.
MRS. WINSLOW'S SOOTHING SYRUP This deadly concoction was used to relieve teething pain. Containing alcohol and 65 milligrams of morphine per ounce, it did indeed help restless infants sleep — the problem was that many never woke up. In 1911, the syrup was labeled a “baby killer” by the American Medical Association but continued to be sold as late as 1930. It is now considered to have caused significant infant mortality during the period.


HAMLIN’S WIZARD OIL
Developed by former magician John Hamlin, this panacea contained roughly 60% alcohol along with chloroform, turpentine, ammonia, cloves, sassafras and camphor. Hamlin initially peddled the oil as an external liniment and topical remedy for toothache and earache, but later encouraged its ingestion to cure headaches, diphtheria, pneumonia, rabies and cancer. If you weren’t sick before taking it, chances are you would be afterward.

DR. SAGE’S CATARRH REMEDY Featuring grand vistas of Niagara Falls (talk about drainage!) and a sign painter dangling on a board flimsier than the science backing up this remedy for mucus buildup, this advertisment raises the already perilous stakes for quack medicine. 4

DR. D. JAYNE’S ALTERATIVE
A one-stop shop for all your disease and sickness needs, Dr. D. Jayne’s Alterative claimed to cure a smorgasbord of afflictions, from pimples and carbuncles to cancer and rheumatism — not to mention scrofula and dropsy. There’s nothing like pushing some tigers off a cliff to let the world know, “Hey! Have we got a cure for you.”
“Advances in color printing, lithography and mass production raced far ahead of regulatory oversight of patent and other ‘medicines.’ But just because they looked good to the eye didn’t mean these remedies were in any way good for you.”
WILLIAM DEVERELL DIVISIONAL DEAN OF SOCIAL SCIENCES AND PROFESSOR OF HISTORY, SPATIAL SCIENCES AND ENVIRONMENTAL STUDIES

For cancer researcher Peter Kuhn, the battle against the disease is profoundly personal as well as scientific.
Kuhn’s mother was diagnosed with breast cancer when she was 48. Though treatment was successful, Kuhn watched her live for decades with the terrifying specter of its return. With every small ache and pain, she worried the cancer might be back — and 33 years after her first diagnosis, it recurred.
“Think how often you have an ache or pain, and multiply that out over 33 years,” says Kuhn, University Professor and Dean’s Professor of Biological Sciences at USC Dornsife.
Driven by a commitment to ease the burden for millions of people at risk of cancer, Kuhn pioneered a “liquid biopsy”
to detect cancer cells in the bloodstream. The blood test, a minimally invasive alternative to tissue biopsies, has become an important tool in the management of late-stage cancers. It helps doctors customize treatment plans with precision, aligning drug therapies with the unique profile of each patient’s cancer.
Ten years ago, when Kuhn first arrived at USC Dornsife as a founding member of the USC Michelson Center for Convergent Bioscience, he doubted his test would be able to detect earlystage disease. “I thought, ‘If there’s cancer in the blood, the train has left the station’” — meaning that the disease has advanced to the point that it has hitched a ride to other locations in the body.
Fast forward to today: That prediction
has been turned upside down.
“We can, in fact, find early signs of cancer in the blood,” says Kuhn, who also has joint appointments in medicine and urology at Keck School of Medicine of USC and in biomedical engineering, aerospace and mechanical engineering at USC Viterbi School of Engineering. “Sometimes it’s not necessarily the cancer itself we’re detecting, but signs of an initial interaction between the emerging cancer and the surrounding tissue or the emerging cancer and the immune system.”
Considering that early detection can boost a patient’s chance of survival, Kuhn’s blood test has huge potential. His team at the Liquid Biopsy Clinical Laboratory, located in the USC Convergent Science Institute in Cancer (CSI-Cancer), is now investigating if his liquid biopsy can be a complement to and boost the performance of mammograms. If it can, the simple blood draw promises to make screening for new cancers and recurrences more accessible and routine.
“The blood test can be done every few months throughout life,” Kuhn says, noting that other screening tests like mammograms and CT scans aren’t typically performed with such frequency. “Developing a way to screen for cancer across the lifespan was always my ultimate goal.”
True to the convergent science model he helped establish at USC, Kuhn — recently named a senior member of the National Academy of Inventors — collaborates with experts in machine learning and artificial intelligence from USC Viterbi School of Engineering to revolutionize the field. At the intersection of technology and medicine, researchers in his lab take thousands of images of each blood sample they analyze. Teaching machines to spot the most relevant signals in the images expands the scope and pace of the analysis exponentially.
“As a scientific community, we’re creating better outcomes for everyone — those with cancer and those at risk,” Kuhn says.

Junior Anya Shah was diagnosed with leukemia at age 8. Since freshman year, the global health major and USC Dornsife natural sciences minor — who is earning her master’s in narrative medicine through the Progressive Degree Program — has been working at CSI-Cancer. There, she analyzes fluorescent images of blood samples collected from individuals undergoing a diagnostic workup for lung cancer. Her work identifying a variety of tumor cells circulating in the blood is aimed at increasing the accuracy of those diagnoses, thereby improving patient care.
What motivated you to join the lab?
Being a childhood leukemia survivor led me to my life’s purpose, which is to become a physicianscientist, treat patients and research cancer interventions. Joining Peter’s lab to understand and explore the use of precision medicine in advancing oncology felt like a perfect fit.
What do you enjoy most about the research?
Knowing that there’s so much potential to detect cancer sooner is very exciting. The goal of directly impacting patient outcomes through this research has been incredibly meaningful given my background.
What is the most important thing you’ve learned?
One thing that this environment has emphasized to me is the significance of collaboration and convergence, both of which are pivotal in advancing our understanding and treatment of cancer.
What is unique about working in the lab?
The people around me are pretty incredible. I’ve learned so much just in peer-to-peer conversations and through the direct transfer of knowledge from experts in the field.
Has working in the lab impacted your future goals? It’s been life-changing to see how exhilarating and cutting-edge medicine can be. It’s really reinforced that I’m on the right path.
A PSYCHOLOGY PROFESSOR AND A PROFESSOR OF BIOLOGICAL SCIENCES AND ANTHROPOLOGY DEBATE THE ISSUE.
“Technology is revolutionizing our approach to health.”
Technology is reshaping how we understand, manage and enhance our health and well-being in ways that were previously unimaginable.
Technology not only improves diagnostic capabilities and supports the development of new therapeutics but also reshapes our daily wellness routines. Exercise apps and online Pilates classes are just the beginning. For example, virtual reality headsets transform routine workouts into an engaging game, and platforms like Peloton build community and accountability among users — a key driver of sustained practice.
Wearable devices such as Fitbits track a wide array of health metrics that enable us to monitor our heart rate, blood pressure and sleep cycles, offering insights that can lead to healthier habits. Technology also enables us to easily tailor treatment, exercise and nutrition to individual needs, making it possible, for example, to send your day-today food intake to a provider for personalized feedback.
One of the greatest health-related gifts of technology is access to information that enables us to advocate for our health from an informed perspective. Technology can also support preventive health, recommend whether we need to see a health care provider and even facilitate the scheduling of an appointment. More than that, it’s aiding scientific breakthroughs in the understanding and treatment of numerous illnesses.
Telemedicine and telehealth capabilities make it easier than ever to access mental health care, which was particularly important during the pandemic when rates of anxiety and depression soared. In my research investigating treatments for depression, I’ve seen firsthand the power of technology to not only reduce stigma around mental health, but also reach those who previously lacked access to interventions. Technology facilitates meaningful relationships among individuals, enhancing their support networks.
While there are legitimate concerns about technology’s role in promoting sedentary behaviors and its potential negative effect on mental health through increased screen time and social media use, I contend that the overarching benefits, particularly in health care innovations and wellness tracking, cannot be ignored. By enhancing the accessibility, enjoyment and effectiveness of health care services and promoting activities conducive to well-being, technology is playing an indispensable role in fostering a healthier society.
Iony Ezawa, assistant professor of psychology, harnesses digital technologies in her research on depression and anxiety to improve access to treatment and to determine effective, individualized care.


David
Raichlen, professor of biological sciences and anthropology, is director of USC Dornsife’s Evolutionary Biology of Physical Activity Laboratory and an expert on the effects of sedentiary behavior.
“Technology is encouraging an epidemic of sedentary behavior that may impact our physical and mental health. ”
When we consider technological advancements that have had the biggest negative impacts on health, we generally think of televisions and smartphones. I contend that these technologies are making us less healthy primarily because they encourage us to engage with a much earlier invention that dangerously impacts our health: the chair.
For nearly 2 million years, ancestral humans sat, kneeled and squatted on the ground, using their muscles to balance and adjust their posture in constant motion. Around 5,000 years ago, humans invented chairs, which allow us to rest with little to no muscle activity and very low energy expenditure. Because of this, long periods spent sitting are linked with a wide range of diseases and have become a major focus of public health research. While the comfort of chairs may be enticing on its own, an increase in screen-based activities is compelling us to spend more time sitting than ever before.

Many of our jobs have become deskbound and computer-based. The reserach indicates that due to our greater reliance on technology, we are less physically active in our workplaces, and this may be associated with increased obesity. Additionally, in just the last 20 years, leisure time sedentary behavior in adults and adolescents in the United States has increased by 20% to 25%. Technology may be a key contributor to this trend.
Across our lifespan, TV viewing accounts for a large proportion of sitting time and is linked to an increased risk of cardiovascular disease, diabetes and even mortality. Smartphone use also contributes significantly to prolonged sitting, exacerbating risks to our cardiometabolic health.
Our own research suggests that sitting may also affect brain health, but modern technology influences how these effects manifest. For example, we discovered that not all sitting behaviors have the same impact on the brain: Mentally passive activities, like watching TV, are associated with an increased risk of dementia, whereas engaging in mentally stimulating activities, such as using a computer, may actually protect against these declines in brain health.
In addition, numerous studies have demonstrated that using smartphones, which we often do while sitting, can negatively impact mental health.
For example, longer times spent in screen-based sedentary behaviors, but not total sedentary time, are associated with worse mental health in college students. These links between screen-based sedentary time and mental health are consistent across the lifespan but may be most concerning in adolescents.
So, what can we do about this? While we crave comfort for good reason, challenging ourselves to sit less is one way to improve our heart and brain health, and turning off our devices will minimize the temptation to sit. When we are sitting, engaging in cognitively active, constructive behaviors can either mitigate some of the negative aspects of sitting or even provide brain benefits.



After a year’s hiatus, USC Dornsife Magazine is back! Welcome to the first issue of your freshly minted alumni magazine — the result of an extensive redesign created in partnership with design consultant Kelly McMurray, founder and creative director of 2communiqué. The greater variety of storytelling, professional photography, innovative new sections, and return of Alumni News are a direct response to your thoughtful feedback. You told us what you liked, what you didn’t, and what you wanted to see more of — and we listened. On our cover, we’re thrilled to feature the work of Aaron Tilley, a hugely talented London-based photographer who has created stunning images for The New York Times, Vogue and The Financial Times. He beautifully expresses the delicate
balance of elements necessary to cultivate optimum health and well-being — exercise, nutrition, sleep, health care and scientific innovation. All are explored in this issue, with a particular emphasis on the latter. Read our features to discover what our scholars are doing to improve longevity, battle dementia, overcome pain and addiction, and end health inequalities. We hope you enjoy the read and wish every one of you the very best of health!
SUSAN BELL Editor-in-Chief
Our experts share their
longer, happier and healthier life.
research insights on how to live a ILLUSTRATIONS BY TRACI
BY SUSAN BELL AND MARGARET CRABLE

AFTER TURNING 65, the average American enjoys just one additional year of life without significant health issues, according to the World Health Organization. But it doesn’t have to be that way. Adopting the right health behaviors is crucial for extending our years of good health, but sticking with them isn’t always easy — especially when they require significant effort.
Daphna Oyserman, Dean’s Professor of Psychology and co-director of the USC Dornsife Mind and Society Center, is an expert on the psychology behind decision-making. Her research on identity-based motivation sheds light on what drives our decisions and offers some important tips on how to make the best choices for our health and well-being.
According to Oyserman, one important factor influencing our decisionmaking or habit-forming processes is whether it feels easy or difficult to imagine ourselves doing the action in question. “When it feels challenging, we might quickly conclude it’s not for us,” she says. “This mindset leads to a self-defeating prophecy: We fear we will fail and thus opt to not waste time trying. As a result, we invest less effort or shift to something else.”
Oyserman argues that rethinking our response to difficulty is essential. “Many important, valuable things are hard to execute. Shifting our mindset to view challenges as a natural and essential part of achieving valuable goals makes it more likely we’ll embrace them. Think about it as ‘no pain, no gain.’”
Applying this principle to health behaviors, which often demand consistency and repetition, makes it easier to commit to habits that foster well-being. Recognizing that it’s inherently difficult to maintain such habits for their long-term benefits can motivate us to stick with them and improve our quality of life. “If each habit feels hard and I tell myself, ‘It’s not for me; I don’t want to waste my time,’ I’m simply going to be much less likely to do healthy things,” Oyserman says.
The alternative is to consider that important things in your life — such as healthy behaviors that will increase longevity and well-being — are actually worth engaging in.
The implications of this mindset extend beyond the present, highlighting the importance of establishing good habits early in life. Research suggests it’s beneficial to start as soon as possible, particularly during the pivotal years of adolescence.
Oyserman’s research extends into middle-school classrooms, where she examines the effects of identity-based motivation on eighth-grade students. Through a six-week program, students engage in activities designed to internalize the “no pain, no gain” concept. The outcome? These students tend to outperform their peers academically, show increased engagement with their schoolwork and, notably, exhibit fewer symptoms of depression.
In adults, Oyserman’s research on self-perception — including selfefficacy, self-esteem and self-compassion — reveals that individuals who view difficulties as impossible obstacles generally experience lower levels of these traits. Conversely, those who see challenges as opportunities for growth report higher levels in all three areas.
Yet, Oyserman points out, both perceptions can play a positive role in our decisions relating to health and well-being. Her findings suggest that maintaining flexibility is key. “What really matters is the ability to recognize when to step away and when to invest more effort,” she says. “This adaptability can be the deciding factor in both our happiness and health. Sometimes walking away preserves or increases well-being, while at other times, the answer is to roll up your sleeves and dig deeper.”

A long life is best enjoyed with a healthy brain. A growing body of evidence suggests the key to that may lie in our gut. Our stomachs are teeming with trillions of bacteria that are not only essential for digesting food but also communicate with the brain via the vagus nerve, which connects the large intestine to our brain stem. Research shows this connection to have such a great influence on our mental state that our dietary choices can strongly affect our moods, stress levels and even memory. The relationship is so intertwined that scientists have dubbed the stomach our “second mind.”
This symbiotic relationship between the brain and the gut has been crucial throughout human evolution. “For our early ancestors, remembering events and details related to eating supported their survival, guiding foraging and consumption behavior,” says Scott Kanoski, a professor of biological sciences who studies the link between diet and brain function.

Because of this close relationship, our eating patterns have an outsized impact on our cognitive functioning. Kanoski’s recent study involving rats revealed that the consumption of either sugary beverages or artificially sweetened drinks during adolescence could impair memory in later life. These findings suggest that making simple changes, like swapping soda for still or sparkling water might be a good first step to preserving cognitive function over time.
Determining the best diet for brain health can be confusing, considering the plethora of conflicting dietary advice. In fact, when it comes to foods to boost brain function and memory, the evidence is more definitive about what to avoid.
To keep our minds firing on all cylinders, Kanoski recommends we swap the refined carbohydrates contained in white bread for whole grains, minimize consumption of saturated fats such as those found in fried foods, and avoid ultra-processed foods like chips and hot dogs.
Enhance your well-being with these popular self-care practices from around the world.
1
FOREST BATHING OR “SHINRIN-YOKU” (JAPAN) This popular pastime involves immersing oneself in nature and focusing on sensory engagement. Reputed benefits include reduced stress, lower blood pressure and improved immune function. “As two-thirds of Japan is covered by forests, perhaps it isn’t surprising that this practice originated there,” says Duncan Williams, director of USC Dornsife’s Shinso Ito Center for Japanese Religions and Culture.
2
SAUNAS (FINLAND AND SWEDEN) Thought to have originated 10,000 years ago, the tradition of the sauna is reputed to improve cardiovascular and mental health, socialization, exercise performance and muscle recovery. Saunas may also alleviate chronic pain and fatigue, reduce the risk of stroke, respiratory disease and dementia, and promote relaxation, stress reduction and better sleep.
3
INSECT-BASED NUTRITION (ASIA, AFRICA, LATIN AMERICA) Insects are a sustainable, nutritious and high-protein food source that offer health benefits. Some even find them delicious. According to the National Institutes of Health, approximately 2,000 insect species are consumed in at least 113 countries. Michael Petitti, associate professor (teaching) of writing, notes that “chapulines” — grasshoppers fried in garlic and chili and garnished with lime, which he introduces his students to at an East Los Angeles market — may seem like a novelty item to many. “But they also could represent the future of food,” he says.
4
WILD WINTER SWIMMING (BALTIC STATES, RUSSIA, NORDIC COUNTRIES) Taking a dip in an icy cold sea or lake has long been a New Year’s tradition in many parts of the world, but the practice of regular wild swimming during the winter months is growing in popularity. Devotees say it improves mood, increases cardiovascular and metabolic health and strengthens the immune system — and the research concurs.
5
VORFREUDE (GERMANY) The German concept of “Vorfreude,” which translates as “the anticipation of joy,” is reputed to help increase well-being, reduce stress and avoid burnout. “You don’t have to wait for ‘grand’ moments, you can plan small, everyday delights to create anticipatory joy that will enable you to benefit from Vorfreude,” says Britta Bothe, professor (teaching) of German.

We’re accustomed to turning to scientists and health care practitioners for health advice, but could religion have some ancient wisdom to offer about longevity?
Fasting is an integral part of many faiths. Muslims abstain from food and drink between sunup and sundown during Ramadan. Lent marks a period of regular fasting for Christians.
“Fasting has been recognized in Buddhism since its inception, not only for its physical health benefits but also for awakening the mind to nirvana or cosmic consciousness — a state of bliss,” says Thomas Ward, professor (teaching) of anthropology and an expert on Tibetan Bön Buddhism.
These spiritual practices align more closely with scientific recommendations than some might expect. Research by Valter Longo, professor of gerontology and author of The Longevity Diet, has found that fasting might actually help to extend our lifespan.
The good news is that you don’t have to abstain completely from food to get the benefits. In Longo’s program, patients eat their regular diet each month except for five consecutive days when they follow a reduced-calorie meal plan high in plant-based complex carbohydrates, healthy fats and protein.
Longo’s studies suggest that this “fasting-mimicking diet” shows promise to positively impact our health.
“Keck Medicine of USC and many
other hospitals around the globe have completed a number of trials indicating that repeating this diet over at least three cycles reduces biological age as well as blood markers for aging and cardiovascular disease,” says Longo. “It also shows potential for reversing both late-stage type 2 diabetes and for increasing overall survival in triple-negative breast cancer patients.”
Religion may have more helpful advice to offer on how to improve health and well-being. Buddhists and Hindus have practiced meditation for thousands of years. Researchers are now finding that this form of mindfulness lowers levels of chronic stress and could even slow cellular aging, although further studies are needed.
The world is awash with health tips, but which ones are worth following? Our experts weigh in.
MORNING LIGHT FOR BETTER SLEEP?
The dark mornings and bright evenings of Daylight Saving Time don’t align with the internal clock that regulates our sleep cycles, says Steve Kay, University and Provost Professor of Neurology, Biomedical Engineering and Quantitative and Computational Biology. He recommends getting sun exposure as early in the morning as possible and at night, dimming screens on electronic devices to minimize disruptive blue light.
KEEP A GRATITUDE JOURNAL?
A thankfulness routine is well worth the effort, says Glenn Fox ’14, assistant professor of clinical entrepreneurship at the USC Marshall School of Business and an expert in the science of gratitude. He notes that “gratitude is linked to several health benefits, including better sleep, increased physical activity, lessened pain symptoms, and lower blood pressure and inflammation levels.”
AIM FOR 10,000?
The 10,000 steps-a-day goal actually began as a marketing campaign for a Japanese pedometer in the 1960s, says David Raichlen, professor of biological sciences and anthropology. Studies now indicate that any increase in the number of steps you normally take will generally improve your health.
ADD SALT TO MY WATER FOR BETTER HYDRATION?
This may be beneficial, says Grayson Jaggers, associate professor (teaching) of biological sciences. Sweat contains both salt and water and it’s important to replenish both as you lose them. Too much sodium leads to high blood pressure, however, and foods also provide salt, so don’t overdo supplementation.
SWITCH TO A STANDING DESK?
Standing desks may offer some health benefits, such as helping to regulate blood sugar after meals, but they aren’t a cure-all for sitting-related health issues. They also may cause discomfort if used excessively. Alternating between sitting and standing, and staying active are best for maintaining overall health, advises Raichlen.
IS RAW MILK HEALTHIER THAN PASTEURIZED?
Jaggers says no. The science shows that the pasteurization of milk has no significant, negative impact on its nutritional quality but does increase its safety. Unpasteurized milk is among the riskiest foods, and consuming it can have life-threatening consequences.
Four life peaks we reach after 40.
Contrary to popular belief, growing older is not all gloom and doom, far from it.“People worry about growing old because our image of old age is dominated by decline. But the expectation that everything will get worse as we get older is simply false,” says Norbert Schwarz, Provost Professor of Psychology and Marketing. “Particularly in North America, Europe and more affluent societies of Asia, life gets better as we age.”
In fact, growing older means we can look forward to hitting several peaks in cognitive ability, not to mention becoming happier and quite possibly nicer. There is also an increased chance of winning an ultramarathon — and even that coveted Nobel Prize.
So, could your prime still be ahead of you? Here are some peaks to look forward to in later life.
RUNNING ULTRAMARATHONS Ultrarunners peak far later than other athletes: between 40 and 44 for women and 45 to 49 for men, according to a 2020 study of runners who completed 100km ultramarathons. And the longer the race in either distance or duration, the older the runners with the peak performance. There are even ultramarathon winners in their 70s.
COGNITIVE ABILITY The belief that we’re at our sharpest mentally in our 20s and 30s and that it’s all downhill from there is challenged by studies showing that several areas of mental acuity are highest in the second half of our lives. Chess players make the greatest number of “optimum” moves at around age 40. You may have mastered your multiplication tables in elementary school, but research studies show that ability to solve arithmetic problems peaks at about 50. Vocabulary reaches its zenith even later, in our late 60s or early 70s. And if you’re aiming to win a Nobel Prize, you can take comfort from the fact that most winners who receive the ultimate accolade do so in their early 60s.
HAPPINESS Study after study confirms it: Happiness declines from youth to middle age and increases again into old age. “The expectation that happiness continues to decline after your 30s is wrong — it goes up again as you get older, continuing into old age,” says Schwarz. The reason? “Once we retire, a lot of the stresses of daily life, such as parenting, pursuing a career and striving to advance, are gone. You are free to spend your time with people you like and engage in leisure activities you enjoy.”
AGREEABILITY Research suggests adults become more agreeable with age. “Older people are nicer in social interactions, perhaps partly because they can be more selective in whom they interact with,” says Schwarz. He notes that older people tend to avoid situations — and people — that cause them distress.
A long and healthy life may require a little help from our friends. That can be challenging. In 2023, the U.S. Surgeon General referred to a “loneliness epidemic.” Even before the COVID-19 pandemic, nearly one in two Americans reported significant feelings of loneliness.
The condition has serious implications for public health: Prolonged social isolation is associated with an increased risk of stroke, diabetes, cardiovascular disease, dementia and premature death.
A new study by Morgan Lynch, a doctoral student in psychology, discovered that the loneliest older adults exhibited poorer cognitive function and accelerated signs of aging. While it’s still unclear whether perceived social isolation directly contributes to the development of dementia or if individuals with cognitive decline find it harder to socialize, there is a genetic link to loneliness, as there is to dementia. However, Lynch notes, it’s not all up to fate. “While we can’t change our genetics, we can mitigate about 50% to 60% of our risk for loneliness and dementia through lifestyle choices,” she says.
But making social connections is increasingly challenging. Declining interest in traditional pillars of community, such as marriage and religious gatherings, coupled with our skyrocketing propensity to spend time online, has contributed to a record number of Americans living alone and having few close friends.
USC’s Director of Belonging Cat Moore ’05 is an expert in helping others find community. Her advice for the lonely? Start by creating a “belonging map” to identify where in your routine you regularly see others. This can offer opportunities for building connections, both large and small. Next, take a coworker out for coffee, chat with a neighbor or exchange hellos with your bus driver.
“The best strategy to keep connected long-term,” Moore says, “is becoming someone who creates belonging wherever they go.”

Music might be one antidote to our increasingly isolated world.
“In an evolutionary sense, we’ve been sitting around fires, playing music and singing for a very long time,” says Assal Habibi, head of the Brain & Music Lab at USC Dornsife’s Brain and Creativity Institute. “It’s one of the basic elements of our health and well-being.”
Habibi, associate professor (research) of psychology, studies how musical engagement affects the well-being of people of all ages. Her research spans the developmental effects of music practice in children to its influence on alleviating loneliness and enhancing memory in older adults.
“My research shows that access to high quality music education is significant for students to flourish and to learn social-emotional skills such as compassion, empathy, perspective taking and
agency,” she says.
Habibi is particularly interested in how musical instruction can improve children’s emotional self-regulation — a skill linked not only to academic success but also to long-term mental health and addiction prevention.
For older adults, even those with no previous music training, Habibi’s work uncovers the transformative power of music. Her findings indicate that seniors who learn how to sing in a choir experience improvement in vitality, anxiety levels, social connectedness and loneliness.
“Study participants, even those in their 70s and 80s who were initially reluctant to sing, found so much joy and social reward when they engaged with familiar songs and synchronized with others in the choir,” she recounts. “Their shyness and cultural inhibitions disappear.”
Additionally, Habibi’s research suggests that sustained music training can counteract difficulties in discerning speech in noisy environments such as restaurants or family gatherings — a problem that often leads to social withdrawal and loneliness in older adults.
The cognitive and memory benefits of music are significant, as Habibi’s team has discovered. Listening to nostalgic music can help seniors reconnect with their personal histories. This has proved especially therapeutic for those with dementia and mild cognitive impairment by easing the associated anxiety, agitation and depression.
But the benefits of musical activity, particularly in community settings, such as a choir or an orchestra, extend beyond personal enjoyment or therapeutic effects; musical activity fosters community and connection, which are essential throughout our lives.
And it isn’t necessary to become a performer or a conservatory-trained musician to reap the rewards. “I always say, ‘Everyone can sing. Today is the right day to pick up an instrument and learn to play, sing with your family and sign up to join a choir,’” says Habibi. “It’s not too late.” D

In a county divided by heat, USC Dornsife plants the seeds of change.
BY TOMAS WEBER PHOTOGRAPHY BY TIFFANY LUONG

IN SOUTHERN CALIFORNIA, heat divides communities not by mere degrees — it creates different worlds. Here, in this region known for some of the nation’s most extreme temperatures, the experience of a hot day can vary dramatically from one neighborhood to another. Consider a summer afternoon in affluent, predominantly white, treelined Madison Heights in Pasadena, where ancient oaks cast cooling shade over elegant streets and filter pollutants, making the air feel surprisingly pleasant even when the mercury soars.
Contrast this with South Los Angeles, a mere 40-minute drive away, where the demographic shifts to predominantly Black and Latino residents. Park on Vermont Avenue, just south of USC’s University Park Campus, and you’re immediately struck by the stark landscape: Vast expanses of exposed asphalt absorb and radiate the sun’s intensity, making the air shimmer with heat. Here, the oppressive warmth is not just felt; it assaults you, underscoring a tale of two climates within a single metropolitan expanse.
“On the same day, with the exact same weather conditions, the experiences for communities across L.A. County can be tremendously different,” says Manuel Pastor, Distinguished Professor of Sociology and American Studies and Ethnicity and Turpanjian Chair in Civil Society and Social Change at USC Dornsife.
People of color and those with low incomes are more likely to live in neighborhoods without shade, notes Pastor, who leads USC Dornsife’s Equity Research Institute (ERI).
In neighborhoods such as East Hollywood, South L.A. and Pacoima, temperatures can soar up to 10 degrees higher than in more affluent and predominantly white areas nearby. This phenomenon, known as the “heat island effect,” worsens as the climate warms, putting residents of these areas at greater risk of heatstroke, heart attacks, strokes and other heat-related illnesses.
This disparity extends beyond just temperature. Take the impact of air pollution on people of color, who are more likely to live perilously close to freeways and toxic industries. The heightened exposure to pollutants puts them at greater risk of respiratory illnesses and lung cancer — and poses a particularly dire threat to children.
“The most significant and consistent predictor of higher exposure to air pollution is not income,” Pastor says. “It is race.”
ENVIRONMENTAL INJUSTICE
From the way toxins can interact with our genes in utero to a childhood spent next to a highway, researchers increasingly recognize the intricate relationship between our environment and our health. In USC Dornsife’s new Developmental Origins of Health and Disease program, run jointly with Children’s Hospital Los Angeles, graduate students work alongside faculty to investigate how factors outside the body — whether occurring in the environment, in society or across generations — can cause disease.
But finding solutions to close deeply

rooted environmental equity gaps, and their interrelated causes, is far from straightforward. Paulina Oliva, associate professor of economics at USC Dornsife, is developing tools to help policymakers understand, at a granular scale, how air pollution affects communities in disparate ways.
She points out that residents of areas plagued by higher levels of air pollution often face a double jeopardy: Not only do they typically have limited access to health care, but they also lack the financial resources necessary for adequate recovery time from illnesses.
“If I get sick because of exposure to air pollution,” says Oliva, “I might be fine because I can stay home and take care of myself. But for a low-income
person who can’t do that, their health could be disproportionately damaged.”
This intertwining of environmental harm with socioeconomic disparities presents a significant challenge for researchers. It complicates efforts to study the direct effects of pollution because the compounded impacts on less affluent communities are difficult to separate and analyze in isolation.
When it comes to reducing the environmental equity gap, what balance should policymakers strike between improving air quality and increasing access to health care? Oliva is developing tools to help policymakers break down the complex causes of environmental inequities, thereby supporting the creation of more effective interventions.

One solution to environmental inequity?
Plant more trees. USC’s Urban Trees Initiative, launched in 2020 by USC Dornsife’s Public Exchange, aims to reduce environmental disparities across L.A. by helping the city and local nonprofits plant more trees in heat islands and pollution hotspots. In 2023, the Bezos Earth Fund awarded $2.9 million to Pastor and John Wilson, director of the USC Dornsife Spatial Sciences Insitute (SSI) and professor of sociology, to counter some of climate change’s negative impacts and to narrow existing environmental equity gaps plaguing cities across the United States.
Working as part of the USC Urban Trees Initiative, SSI is using geospatial
the City of Los Angeles to develop a scorecard that ranks trees according to how well they cool the streets and filter pollution.
“We go out and basically interrogate a tree,” says Berelson, professor of Earth sciences, environmental studies and spatial sciences. “We put a sensor in it and measure the canopy air quality to determine how effective it is under different conditions.”
Pastor’s work overlaps with the Urban Trees Initiative’s mission. For more than a decade, his team has worked with PolicyLink to develop the National Equity Atlas, America’s most comprehensive map of racial and economic equity. Today, ERI is expanding on this work by gathering data on environmental indicators and climate risk, including heat maps and tree canopy coverage, to pinpoint areas most in need of intervention.
In neighborhoods such as East Hollywood, South L.A. and Pacoima, temperatures can soar up to 10 degrees higher than in more affluent and predominantly white areas nearby.
tools and data analysis to determine which areas within vulnerable communities would most benefit from additional tree canopy.
Pastor and Wilson note that, thanks to the Bezos Earth Fund, they are planting the seeds of equity and resilience. Their work, a fusion of strategic tree-planting, advanced geospatial methods and social justice, isn’t just shaping urban landscapes, it’s enhancing community well-being.
Another key step? Understanding which trees to plant. William Berelson, Paxson H. Offield Professor in Coastal and Marine Systems, is part of the Urban Trees Initiative, collaborating with
At the forefront of Pastor’s mind, though, is finding ways to foster healthier environments while protecting communities from “green gentrification.” This, Pastor says, is why conversations with residents about their wants and needs are driving both the National Equity Atlas and the Urban Trees Initiative.
“A large part of our work is listening to environmental justice leaders throughout the United States,” says Pastor.
“We ask, ‘What would be a useful piece of data for environmental justice and health equity in your communities?’
“We are always conscious of the power and importance of community voices.” D
Narrative medicine uses humanities tools to train medical students to be better listeners—and as a result, better doctors.
BY MEREDITH MCGROARTY
ILLUSTRATION BY ANNA GODEASSI

WHEN PAMELA SCHAFF ’19, director of USC’s Master of Science in Narrative Medicine Program, was working toward her PhD in literature and creative writing at USC Dornsife, she studied the complex ways in which Henry James depicted relationships between characters in his novels. Schaff says the close reading of such texts during her doctoral research enhanced her clinical skills, as well as her ability to interpret the joys and struggles of her patients, and to act on their behalf — two key areas of practice that narrative medicine aims to bolster.
Students in the Narrative Medicine Program learn that the ancient medical tradition of beginning an examination by “taking a history” to understand a patient’s story does not account for what happens during the clinical encounter. There is a key distinguishing factor when practicing narrative medicine called “narrative humility.” The concept recognizes that a patient’s story is not one that can be mastered but instead is dynamic and requires listeners to reflect on what they bring to an encounter. It also requires them to be open to the
transformation that occurs when we hear another’s story.
The Narrative Medicine Program builds on this foundational practice by equipping students — future physicians, social workers, psychologists, nurses and those aspiring to work with health-related nonprofits — with a comprehensive range of humanities-based skills to engage with patients. These tools are designed to help graduates gain a more holistic understanding of an illness, including the contextual life circumstances and patient anxieties related to it.
While the program is housed at the Keck School of Medicine of USC, courses are taught by faculty with appointments at USC Dornsife and with specialties outside of biomedicine and clinical work. By drawing from such disciplines as creative writing, sociology, philosophy and anthropology, students learn how to “read” a patient’s account of their illness, appreciate their fears regarding prognosis or treatment, and communicate news and information in a manner that is most effective for patient well-being.

Students immerse themselves in diverse works of poetry, film, fiction and theatre that invite them to grapple with the uncertainty and complexity of the human condition. Works such as Claudia Rankine’s Citizen: An American Lyric, Ocean Vuong’s On Earth We’re Briefly Gorgeous and Alison Bechdel’s graphic memoir Fun Home invite students to reflect on individual and community identity.
“Close attention builds trust. It opens a space where patients, perhaps initially hesitant about vaccinating their kids or worried about developmental issues, will truly feel seen and cared for — an experience that’s rare in the rush of a standard 15-minute appointment,” says Schaff, professor of medical education, family medicine and pediatrics and director of Keck School of Medicine’s Humanities, Ethics, Art, and Law (HEAL) Program.
One recent graduate of the Narrative Medicine Program, Kathy Riley, is now associate director of programs at Cancer Support Community Los Angeles. She attributes her proficiency
in addressing the complexities of grief and loss — a significant part of her work with caregivers — to the skills cultivated through the program. She notes caregivers are often overlooked in the context of illness and treatment and helping them address their feelings is vital for their well-being.
The field of narrative medicine is now widening far beyond the doctor’s office. Using stories to better understand subtexts and perspectives is also proving useful in the realms of social justice, law and myriad other areas, notes Erika Wright ’09, associate director of the Narrative Medicine Program.
Wright, assistant professor of clinical medical education and English, earned a PhD in English from USC Dornsife and also serves as an instructor in the Narrative Medicine Program. She says, “Learning how to understand complex community narratives, as well as recognizing that each individual within a particular community has their own story, is key to being able to best help an individual — whether in the doctor’s office or beyond.”

The number of people living with Alzheimer’s is expected to triple by 2050, while a common early sign of the disease is alarmingly underdiagnosed. In the race to defeat dementia, physicists, biological scientists and psychologists are finding surprising clues to understanding the drivers of the disease and how to prevent and treat it.
BY KATHARINE GAMMON ILLUSTRATION BY NOMOCO
JEAN AND MIKE BLAND have been married for 41 years. They found each other after difficult first marriages and immediately fell in love. But a few years ago, Mike began to notice changes in Jean’s behavior: She was getting confused while driving in her familiar hometown of Oceanside, California.
He initially dismissed her confusion as a normal part of aging — after all, they were both in their late 70s at this point. But there were other worrisome changes in Jean’s behavior. A former nurse, Jean was in the habit of showing up at doctors’ appointments with a carefully compiled list of questions. But now she no longer did this. The doctors suggested testing her cognition and found that Jean had mild cognitive impairment (MCI), a condition that may be an early sign of Alzheimer’s disease.
The diagnosis “scared me to death,” Jean says. “I really didn’t know how to handle it at first. So, I had to think about it, read about it and then eventually admit that something was wrong.” She is now taking one of the new drugs that can slow cognitive decline. But because it’s only effective when taken early, it’s fortunate that she was diagnosed when she was.

At USC Dornsife, researchers are studying dementia and Alzheimer’s not only to understand how to prevent them but to discover treatments. The urgency of their mission is underscored by the daunting statistics: 47.5 million people worldwide are living with dementia, with 7.7 million new cases emerging annually. Without groundbreaking medical advances to halt cognitive decline, the number of people living with Alzheimer’s is expected to triple by 2050.
Because people commonly chalk up mental changes to normal aging, the diagnosis of MCI — which can be an early sign of Alzheimer’s — is often missed. A recent study by Soeren Mattke, director of the Brain Health Observatory at USC Dornsife’s Center for Economic and Social Research, found that MCI is alarmingly underdiagnosed: Among Americans 65 and older, 7.4 million are unknowingly living with the condition. Even more startling, half of these individuals are silently battling Alzheimer’s disease.
Mattke and his colleagues analyzed data from 40 million Medicare beneficiaries and compared the proportion diagnosed as having MCI with the expected rate for this age group. They found that fewer than 8% of expected cases were actually diagnosed. A second study looked at more than 200,000 individual primary care clinicians and found that 99% of them underdiagnosed MCI.
Symptoms of MCI are mostly forgetfulness and struggles with tasks, such as balancing a checkbook or following a recipe, that require executive functioning. Underdiagnosis is commonly associated with patients not wanting to discuss their challenges with their doctor and short clinical visits with no discussion of brain health.
The study is a wake-up call to identify MCI early, says Mattke, professor (research) of economics.
“Once you’ve lost brain cells, they are irreversibly lost,” he says. “And this is why we need to find these cases very, very early on in this MCI phase so that we have the potential to treat it.”

Researchers at USC Dornsife are also using synthetic biology to better understand the changes in brain structure that signal the onset of Alzheimer’s.
Thanks to a joint gift of $50 million from the Epstein Family Foundation to USC and the University of California, San Diego, the recently created Epstein Family Alzheimer’s Research Collaboration is driving Alzheimer’s research at both universities, accelerating the search for better treatments and a cure.
At the heart of this effort, USC Dornsife physicist Peter Chung, Robert D. Beyer (’81) Early Career Chair in Natural Sciences, has been exploring one of the hallmarks of Alzheimer’s — the brain’s tau protein formations. When tau proteins, which typically support and maintain neuron structure, become defective, they form into “tangles.” These tangles are harmful as they lead to nerve cell damage and inflammation, laying the groundwork for Alzheimer’s symptoms. Until now, the only methods available to study tau tangles have presented researchers with significant challenges. To better understand these abnormal protein accumulations within brain neurons, Chung and his colleagues are engineering synthetic versions that precisely replicate the tangles’ structure as seen in Alzheimer’s patients. They are also creating a laboratory model that will enable the rapid evaluation of numerous chemical compounds. Their goal? To discover groundbreaking treatments capable of dissolving tau tangles, offering hope to Alzheimer’s patients by potentially slowing the progression of the disease — or even stopping it in its tracks.

As director of USC Dornsife’s Evolutionary Biology of Physical Activity Laboratory, David Raichlen is interested in many issues relating to physical activity and
brain health. Curious about modifiable lifestyle behaviors — changes that might be more attractive to people than physical activity — he recently finished a study of time spent sitting. After all, sedentary time was already linked to cardiovascular disease risk and type 2 diabetes; it made sense that it might affect the brain as well. “The impetus was to find out whether behaviors that are easier to modify — like sitting — could have an impact on brain health,” he explains.
Raichlen, professor of biological sciences and anthropology, used data from the UK Biobank and from wristworn accelerometers to classify peoples’ sitting behaviors and discovered something rather surprising: The risk of dementia didn’t respond linearly to the time spent sitting. Instead, he and his colleagues found that there was little risk in sitting up to about 9.5 hours each day — but after that, the risk of developing dementia increased significantly.
While sitting is one of the most natural and common postures for humans, it significantly alters numerous body systems. Weight is taken off the lower limbs and triglycerides build up, which has an impact on the heart. Sitting also reduces blood flow to the brain, which could increase the likelihood of dementia.
The key is to sit less and move around more, Raichlen says. “If people can find ways to reduce sedentary time and increase the amount of time they are active, the payoff may be a delay in the onset of dementia,” he says. “And fortunately, standing up and walking around the house may be easier for people than increasing exercise.”
Because people who sit for long periods of time may have dietary or lifestyle changes that weren’t captured by the accelerometers but could also impact their brain health, Raichlen is continuing his research.
Following on his lab’s previous studies suggesting that passive activities, like watching television while sitting, are worse for the brain than active behaviors
such as using a computer, he also hopes to conduct randomized control trials to understand the mechanisms through which physical activity benefits the brain, amidst a backdrop of various sedentary behaviors.
The relationship between air pollution and dementia is something else Raichlen is actively engaged in researching. Breathing in poor-quality air seems to negate the beneficial impacts of exercise on brain health. Small particles of pollution in the air can enter the body, causing inflammation and stress-induced damage to the brain.

In the search for clues to dementia, answers may lie deep in the traditions of preindustrial societies. Exploring this possibility, an international team of experts has been working in the Bolivian Amazon rainforest, studying the Tsimane and Moseten Indigenous groups. For more than two decades the team has sought insights into the groups’ cognitive health. Seven years ago they were joined by USC Dornsife’s Margaret Gatz, professor of psychology. Together, they are uncovering how the prevalence of dementia among these groups could inform a broader understanding of the disease.
The low incidence of heart disease in the groups suggests the potential for low rates of dementia, given its link to the cardiovascular system. Driven by this hypothesis, Gatz and the team employed an array of tools: CT brain scans, cognitive tests, neurological assessments and culturally appropriate questionnaires, all facilitated by a local team of trained translators and Bolivian physicians, to diagnose dementia and cognitive impairment.
Their findings were striking. Dementia prevalence among the groups’ elderly was around 1% — a stark contrast to 11% among older adults in the United States. With such a significant disparity, Gatz’s research is focused on determining the factors that contribute to the groups’
remarkably low dementia rates.
The low rates may be partly due to vascular health, she says, because there are many aspects of the Tsimane and Moseten lifestyles that contribute to both good heart health and good brain health, including diet and high levels of physical exercise.
Yet, Gatz cautions against oversimplification. “It’s an Indigenous population that is beset by many infections and has low educational levels,” she says, noting the complexity of dementia risk factors. Both inflammation and limited education are, paradoxically, known contributors to increased dementia risk.
One of the challenges in studying Indigenous groups is determining what it means to be cognitively successful in a different society. For the Tsimane, that means fishing, hunting and farming with hand tools and gathering food from the forest throughout their lives. For the Moseten, it means also engaging in agricultural work.
get to be able to compare that snapshot simultaneously with what we’ve learned from studies in the U.S. and Europe. So, this is an amazing opportunity.”
Gatz’s work also sheds light on the complex relationship between familial genetics and environmental factors in the context of dementia. Analyzing data from the Swedish Twin Registry, she and colleagues uncovered compelling evidence that an Alzheimer’s diagnosis in one sibling correlates with a shortened lifespan for other family members, including those who don’t develop dementia. This suggests that the risks associated with developing dementia may be a delicate balance of genes and environmental factors that affect the entire family’s health.
Increasing our knowledge about the causes and underlying factors of dementia can also help to empower those who are managing it today, like Jean and Mike Bland. For Mike, the future is
Mild cognitive impairment is alarmingly underdiagnosed: Among Americans 65 and older, 7.4 million are unknowingly living with the condition. Even more startling, half of these individuals are silently battling Alzheimer’s disease.
“We are meeting people who are incredibly intelligent in their own environment,” Gatz says. “The challenge is understanding the culture and trying to develop assessment methods that take into account the context in which people live.”
In some ways, she says, these studies are also an example of history in action. “It’s an incredible privilege to be able to look at lifestyles of Indigenous people as a snapshot of what might historically have been true of people living in more developed countries,” Gatz says. “You
still unknown — he worries about his own health since he is now a full-time caregiver to his wife. Both he and Jean hope the medication will slow the onset of her dementia, and that research will yield more therapies in the future. With the passage of time, Jean has become a little more confused about following recipes, shopping for groceries, and making decisions. But Mike is sure of one thing: Wherever he goes, Jean will go with him. “We probably hug and kiss more than we ever have,” he says. “Because we know that our time is limited now.” D
How USC Dornsife is writing the formula for the future of medicine
BY KATHARINE GAMMON PHOTOGRAPH BY MAX GERBER
The Human Genome Project, which mapped the entirety of the genetics of our species, was a watershed moment in science. One of the greatest scientific feats in history, the project was a biological voyage of discovery that significantly advanced our understanding of disease, health and the functionality of our bodies, paving the way to improved medical practice. The landmark global scientific effort was based on foundational research by University Professor Emeritus Michael Waterman. Known as the father of computational biology, Waterman joined USC Dornsife in 1982, where he founded one of the world’s first PhD programs in that discipline.
Building on Waterman’s legacy, USC Dornsife created the Department of Quantitative and Computational Biology in 2021, drawing some of the top researchers in the field. We caught up with founding department chair Remo Rohs to talk about ongoing research, the role of artificial intelligence (AI) and why he believes the future of biology lies in computation.
How has computational biology advanced since Michael Waterman founded the field in the early 1980s? Computational biology uses data analysis, mathematical modeling and computational simulations to understand biological systems and relationships. Forty years ago, it was considered a pioneering discipline — today it is fundamental to the field of biology. Not only are we now
able to collect vast quantities of data, but the evolution of biological research demands increasingly sophisticated methods to analyze and interpret this wealth of information.
The field began with genome sequencing in humans and other species. From those beginnings, it has evolved in a number of directions. We now design new drugs by using structural data to figure out how chemical compounds will work. We use mathematical modeling to predict outcomes in cancer. It’s all a part of the interdisciplinary work the department is doing. I am a physicist by training with a PhD in chemistry. Many of my colleagues are mathematicians, statisticians and computer scientists. What unites us is that we all study biological questions.
How is the department’s research improving health care outcomes?
Here is just one example from my lab, where we’re using AI to create new, more effective drugs.
Past drug design was limited to incremental improvements on existing compounds. But now, with the help of AI, we’re identifying proteins or nucleic acids within cells that drugs can affect to treat diseases. And we’re designing previously unknown drugs using machine learning. It’s like finding a new lock and designing the perfect key for it. This means we can create entirely new drugs that are more likely to work and cost less to develop.
In collaboration with colleagues at the USC Michelson Center for Convergent Bioscience, we are already synthesizing some promising new cancer drugs that are based on our work.
What can we expect from the field of quantitative and computational biology in the next 20 years?
Projects across specialties such as molecular biology, evolutionary biology, neurobiology and marine biology already require complex math and computer modeling methods. I believe that all fields of biology will become increasingly reliant on computers, databases, mathematics and statistics. That’s why I call our department “the biology department of the 21st century.”
AI is dramatically altering many areas of research, but it is poised to have a particularly huge impact in computational biology, since the field is already so rich with data. There’s no question AI will drive change in a wide range of areas, from revolutionizing basic scientific research to determining how hospitals are run. Because this is ultimately all about data. And it doesn’t matter so much if we’re looking at a protein structure or a patient file. At the end of the day, AI is a supremely efficient way to analyze data, interpret it and draw conclusions. And that holds tremendous promise for innovation in all areas — from biological discovery to health care. D

BY MARGARET CRABLE
Pain is hurting us. One in five Americans — more than 50 million adults — suffers from chronic, unrelieved pain, making it one of the most pervasive medical problems of our time. According to the National Institutes of Health, this condition costs society up to $635 billion a year in health care expenses and lost productivity, exceeding the costs of heart disease and cancer combined.
But that’s not the only problem. In recent decades, physicians have increasingly prescribed opioids to alleviate both acute and chronic suffering. This has led to a major rise in addiction. Data from the U.S. Centers for Disease Control and Prevention reveals that during a 12-month period ending in 2023, more than 111,000 people in the United States died from drug overdoses. Fentanyl and other synthetic opioids are involved in nearly 70% of overdose deaths, the CDC data shows.
USC Dornsife researchers are taking a two-pronged approach to overcoming this tragic situation by developing effective, nonaddictive pain medications and pinpointing ways to curb opioid misuse and addiction.
“No pain, no gain” goes the saying made popular by 1980s exercise videos. Today, some may scoff at the simplistic sentiment, but our ancestors would probably give it the nod of approval.
Discomfort has long been thought to be transcendence’s twin. For millennia, painful maturation rites, such as facial scarring, marked passage into adulthood. The agony of childbirth brings the joy of new life. And, of course, Christians believe that Christ’s suffering led to humanity’s salvation from its sins.
“Some concepts of well-being actually involve pain, not the elimination of it,” says Peter Redfield, Robert F. Erburu Chair in Ethics, Globalization and Development and professor of anthropology. “Being able to bear pain can be seen as a mark of exceptional heroism, religious devotion or simply the necessary maturity to make it through life.”
Yet, even our most stoic forebears occasionally sought relief, turning to their era’s version of a medicine cabinet: the herb chest.
More than 40,000 years ago, evidence suggests a Neanderthal ingested poplar for relief from an aching jaw abscess. Researchers came to that conclusion after analyzing the dental plaque still present on his teeth when explorers discovered the remains of his jaw in a Spanish cave in 1994. His natural remedy mirrors modern practices, as the tree’s bark contains salicylic acid — the active ingredient central to aspirin’s painrelieving effect.
David McKemy, professor of biological sciences, says we have plants to thank for many of our modern sources of pain relief. “If you look at what’s pharmaceutically available to treat pain, almost every remedy is derived from a plant at some level. They virtually all started with somebody, many centuries ago, chewing on a leaf and experiencing relief.”
Plants have also been instrumental in helping us gain a broader understanding of our perception of pain and sensation. Nobel Prize-winning research
that included work by McKemy, which used capsaicin from chili peppers and menthol from mint, led to the discovery of the protein receptors responsible for our sensations of heat and cold.
McKemy identified the TRPM8 protein as crucial to cold sensation, a finding that may significantly impact headache treatments. His recent study revealed that when this gene was blocked in mice, they didn’t exhibit migraine symptoms. He hopes this discovery will one day bring migraine relief to the one in 10 people globally affected by this condition. (To read more about USC Dornsife’s quest to end migraine suffering, see page 56.)
Other labs at USC Dornsife are exploring promising treatments derived from the cannabis plant to treat neuropathy, or nerve pain, a condition often resistant to conventional medications such as opioids and notoriously difficult to manage.
Our bodies have two receptors that interact with compounds from the cannabis plant to reduce pain. One of these receptors, known as CB2, is active primarily at sites of inflammation and thus shows promise in relieving inflammatory and neuropathic pain. Unfortunately, its close homologue, CB1, is located in the brain and its activation can lead to wellknown psychoactive effects. This makes it difficult to test on patients.
Vsevolod “Seva” Katritch, professor of quantitative and computational biology and chemistry, is researching how to design cannabinoids that selectively target CB2. Two of his recent studies, including one conducted in collaboration with Valery Fokin, professor of chemistry, discovered several new compounds that target CB2. Their goal is to offer powerful relief for those suffering from neuropathy and other pain conditions — without affecting cognitive function.
Historically, the quest for pain relief has encompassed more than just herbal remedies. “Alternative treatments,” as they’re
known today, likely share a timeline as ancient as the use of medicinal herbs. In 1991, the discovery in the Italian Alps of a 5,000-year-old mummy with tattoo marks around diseased and worn joints suggests an early form of acupuncture for pain relief. While acupuncture is still widely practiced and has many enthusiastic adherents, its efficacy is a topic of debate in the scientific community where there is some indication that its benefits may be influenced by the placebo effect.
Doerte Junghaenel, senior research scientist at the USC Dornsife Center for Economic and Social Research, studies the management of chronic pain. She acknowledges the benefits of nonmedicinal alternatives, such as acupuncture, but emphasizes the individuality of pain treatment — there is no one-size-fits-all solution.
She also points out a significant, often overlooked path for pain management: psychological methods. Doctors are increasingly making referrals to pain psychologists a standard part of treatment plans. These psychologists employ therapies such as cognitive behavioral therapy, mindfulness, and acceptance and awareness therapy to combat chronic pain. However, not all patients have easy access to these types of additional treatment.
Junghaenel, associate professor (research) of psychology and gerontology, notes that many people benefit from this holistic approach that encompasses a joint focus on physiology as well as psychology.
“Our mind and our body are powerfully interconnected,” she says. “How people respond psychologically and emotionally has a tremendous impact on their experience of pain.”
In our quest to relieve pain with drugs, we have tragically unleashed a different kind of suffering. Some 2.5 million adults in the U.S. now struggle with the abuse of prescription painkillers. Since 1999, nearly a million people have died due to drug overdoses, largely from opioids.
The number of fatalities due to drug overdoses has been climbing rapidly in recent years due to the powerful synthetic opioid fentanyl, which has flooded the illicit drug market. Just a few, minuscule grains of fentanyl can be lethal. Alarmingly, nearly one in two American adults know someone who has died from an overdose.
Finding new pain medications that aren’t addictive and ways to better treat addiction are vital to saving lives.
Opioids are manufactured from a plant that humans have relied upon for millennia for pain relief: poppies. Evidence of sap from poppy flower pods has been found in Neolithic human encampments dating from the sixth millennium B.C.E.
Opium targets the mu-opioid receptor (µOR), a small protein that dots the surface of nerve cells in our spinal cord and brain. When opioids activate these receptors, it inhibits the release of neurotransmitters that normally help us perceive pain.
Beginning in the early 1800s, scientists harnessed opium to develop a range of painkillers known as opioids, from morphine to the more recently developed fentanyl. These drugs revolutionized health care, significantly reducing the agony of severe injuries, surgery and cancer. However, they also come with serious drawbacks.
Beyond pain relief, µOR activation by opioids releases a flood of “feelgood” chemicals in the brain, triggering euphoria. This pleasurable side effect can unfortunately lead to addiction, with devastating consequences.
Katritch has made promising strides in the development of revolutionary substitutes for opioids. In their most recent breakthrough, published in Nature last year, Katritch and his cross-institutional research partners found that by modifying fentanyl to bind in the sodium pocket on µOR, the drug activated only the receptor’s analgesic properties, eliminating euphoria — and the risk of triggering addiction.
This discovery, as well as Katritch’s research on cannabinoid receptors, was facilitated by research conducted by Vadim Cherezov, Ester Dornsife Chair in Biological Sciences and professor of chemistry. Cherezov’s lab is improving our understanding of the structure and function of proteins such as µOR, helping scientists like Katritch develop better drug treatments.
Their research is underway at USC Dornsife’s Center for New Technologies in Drug Discovery and Development (CNT3D), co-directed by Katritch. CNT3D is focused on cutting-edge drug development, leveraging machine learning, artificial intelligence and the latest advancements in chemistry and biology. The center’s researchers are working on innovative therapeutic solutions for a wide range of conditions, including pain and addiction.
The development of pain medication without euphoric effects would be a significant advancement, but better tools for understanding and managing addiction are equally important.
John Monterosso, associate professor of psychology, specializes in addiction and self-control. He notes a fundamental issue in treating addiction: its propensity to hijack our inbuilt urge to seek pleasure. Our body naturally encourages behaviors that benefit us by releasing pleasurable chemicals such as serotonin and dopamine. From enjoying a nourishing meal to the comfort of a warm hug, we’re biologically wired to seek experiences that evoke pleasure and joy.
Unfortunately, the intense euphoria brought on by opioids, despite the considerable damage it metes out over time, doesn’t register with our pleasurereward system as problematic. Essentially the body just follows standard operating procedure by continuously seeking pleasure. This can make abstaining from opioids particularly challenging, especially as they cause the brain to rewire, resulting in an escalation of craving.
Resisting the siren call of instant gratification often hinges on willpower, a distinctly human trait, says Monterosso.
“You won’t get this from a rat pressing a lever in a lab for cocaine, but a person will sometimes say, ‘This cocaine use is really not making my life better. Even though I have the urge to do it, and it provides immediate reward, I would be better off if I stopped,’” Monterosso says. Of course, choosing to stop is much easier said than done.
Research by Antoine Bechara, chair and professor of psychology, found that the self-control necessary for sobriety may not be uniformly inherent in everyone. He discovered that those with a weaker prefrontal cortex — the brain region associated with decision-making and impulse control — have a higher propensity for substance abuse disorders (SUDs). “Addiction is a disease of decision-making,” he says.
Screening patients for prefrontal cortex dysfunction could be one way to prevent addiction. By proactively identifying patients with a greater risk of addiction, doctors could either prescribe an opioid alternative or track patients
cortex, improving impulse control and helping avoid a relapse.
More transcendental experiences can also spark this neurological restructuring. Psychedelics, a class of drugs that spark hallucinations, have a long history of spiritual and recreational use.
But these experiences also have therapeutic potential, says Katritch. Psychedelic treatment, usually performed in combination with psychotherapy, is also showing increasing promise as a conduit for neural plasticity, positively rewiring addicts’ brains to potentially vault them out of self-destructive habits.
More than 150 recent clinical studies suggest that psilocybin, a hallucinogenic derived from certain mushrooms, can help patients battling a variety of SUDs, as well as other enduring psychological challenges such as PTSD and depression.
“Psychedelics activate the same receptors in our brain as serotonin, the ‘happiness hormone.’ Moreover, recent research shows that it allows the brain to form new neural connections across its different brain regions,” Katritch says.
“Our mind and our body are powerfully interconnected. How people respond psychologically and emotionally has a tremendous impact on their experience of pain.”
more closely for signs of dependency if they are taking an opiate.
The brain’s extensive capacity to modify and adapt itself, an attribute scientists call “neural plasticity,” could also be used to treat SUDs, Bechara notes. Cognitive training can make use of this ability by strengthening a patient’s prefrontal
In laboratory settings, the neural rewiring can be observed within just an hour of administering psilocybin, and persists well beyond the immediate effects. This capacity for creating new brain circuitry remains for months following a dose.
Katritch notes that this neurological
reconfiguration is believed to help the brain ‘relearn’ more efficiently, offering a promising angle for treating persistently negative states such as anxiety, PTSD and addiction.
However, the intense hallucinations that accompany psychedelics pose significant clinical challenges. Psychedelics should be used very carefully and under therapist supervision. The experiences they trigger can be unsettling for some or even harmful to the mental health of certain patients predisposed to psychosis. They also make studying the efficacy of psychedelics tricky. Because patients will unmistakably know if they’ve taken a hallucinogen, researchers cannot use placebos for comparative studies.
To address this, Katritch is investigating synthetic substances that mimic the mind and mood-adjusting qualities of psychedelics without the hallucinogenic side effects, hoping that they also spark neural rewiring. “Mild, nondissociating psychedelics would be a much safer alternative with a huge potential impact on the treatment of mood disorders and addiction,” he says.
Innovative new drug therapies could be a game-changer in alleviating SUDs, but treatment for sobriety will likely always require a comprehensive approach.
Over time, those with addiction may lose many of the most rewarding aspects of their lives — jobs, friends, hobbies — as substances become their sole source of pleasure. Monterosso notes support groups like Narcotics Anonymous can be highly effective in helping to combat the downward motivational spiral that occurs with addiction. Engagement with such groups help those with addictions rebuild social connections and rediscover a sense of purpose.
Emphasizing holistic recovery, Monterosso advises, “It’s vital to build sources of value that outweigh the allure of addiction. That’s why treating the entirety of a person’s life experience is often the most effective way to overcome addiction.” D
YOUR USC DORNSIFE COMMUNITY

Born with a giant tumor in his neck, USC Dornsife alumnus and 2003 University Valedictorian Kevin Huoh underwent more than 60 operations by the time he was 9 years old — most performed by USC-trained doctors who became his childhood heroes. Inspired to follow in their footsteps, Huoh is now a pediatric otolaryngologist whose surgical skills provide lifesaving care to children born with similar conditions.
BY SUSAN BELL


Scan
Pediatric surgeon Kevin Huoh ’03 joins me over Zoom from his home office, “or my man cave,” as he describes it, in Tustin, California, a stone’s throw from Disneyland. Clearly a proud Trojan, the specialist in head and neck tumors sports a cream jacket emblazoned with SC in cardinal and gold, while a framed photograph of the Los Angeles Coliseum is proudly displayed on the wall behind him.
When Huoh leans forward to adjust his screen, a large scar is clearly visible on his neck.
“I definitely have some surgical scars,” he says without embarrassment. “I have a hole in my neck from my tracheostomy tube. I also have two belly buttons — one was where I was connected to my mom, and the other,” he laughs, “was my gastrostomy tube.”
Huoh may have a sense of humor about his disfigurement, but when he was born, his chances of living at all — never mind living a normal life — were, as he says, “very iffy indeed.”
A DIFFICULT START
He was born with a benign tumor in his neck so large that it was obstructing his airway. Doctors initially gave his parents little hope for his survival. They placed a tracheostomy tube in Huoh’s neck to enable him to breathe and a gastrostomy tube in his stomach so he could receive nourishment.
The first six months of Huoh’s life were spent in the neonatal intensive care unit at Kaiser Permanente in Hollywood, just across the street from Children’s Hospital Los Angeles (CHLA), where he would later spend significant chunks of his childhood. In the NICU, doctors advised his parents to place him in a skilled pediatric nursing facility — a course of action that Huoh says would almost certainly have led to his being institutionalized for life.
Fortunately for Huoh — and for his future patients — his parents rejected the doctors’ advice and took him home. However, his ordeal was not over. Huoh may have escaped

institutionalization, but his childhood was marked by dozens of surgeries as doctors endeavored to treat his lymphatic malformation and the associated problems it caused. At CHLA, he underwent so many surgeries before his ninth birthday that he eventually lost count, estimating the number to be between 60 and 80.
As an adult, Huoh has experienced exacerbations of his lymphatic malformation, which can swell, making it hard for him to breathe, speak and swallow.
“There is fear of mortality,” he says. “But also, there’s always this feeling in the back of your mind of, ‘Why me? Everything else in my life is going so well.’” Huoh says he remembers also having those thoughts as a young boy. “When you’re a child, especially, you don’t want to be different,” he says.
But Huoh was different, and visibly so. As a result, he suffered teasing and bullying, particularly in his first years of elementary school.
While crediting his older brother Michael with helping to end the bullying,
Huoh says his own easygoing nature and academic aptitude helped him gain his peers’ respect, significantly reducing bullying incidents after first or second grade.
Despite a traumatic start in life, Huoh’s description of his childhood is surprisingly positive.
“It was normal. Very normal,” he says. “My parents treated me like a normal kid. I played soccer and tennis, violin and piano. I ran around with my older brother, went to a normal school. I think the fact that there weren’t different expectations for me was helpful.”
Nevertheless, he still remembers the fear and the separation anxiety he experienced in the hospital.
“I vividly recall being wheeled off to the operating room, crying and scared, asking for my doctor. Sometimes I refused to leave the room until I saw my surgeon.”
That surgeon was Seymour Cohen, one of the forefathers of pediatric otolaryngology and, like the majority of the doctors and surgeons who operated
“Ever since I was 7 years old, I wanted to be a pediatric otolaryngologist. I even wrote it down in my firstgrade story on ‘What do you want to be when you grow up?’”
on Huoh, a USC-trained and affiliated physician.
Cohen was one of several doctors who inspired Huoh’s childhood ambition to become a physician — and not just any kind of physician. “Since I was 7 years old, I knew I wanted to be a pediatric otolaryngologist,” he says. “I even wrote it down in my first-grade story on ‘What do you want to be when you grow up?’”
When it came time to pick a university, there was only one choice: USC. Many of the doctors who operated on Huoh and had become his childhood heroes were on the faculty at Keck School of Medicine of USC or had trained there. In addition, Huoh’s elder brother, Michael Huoh, who graduated from USC Dornsife in 2000 with a degree in kinesiology, was already enrolled in the eight-year baccalaureate medical program there.
“After all, those USC doctors saved my life. I was also fortunate to be awarded a Trustee Scholarship, which meant a free, world-class education,” says Huoh. “So, for me, going to USC was an absolute no-brainer.”
PATTERN RECOGNITION
Accepted into the baccalaureate medical program at USC Dornsife, Huoh initially chose biological sciences as his major before switching to psychobiology (now neuroscience), with a minor in art history.
That may seem an unusual choice of minor for someone going into medicine, but Huoh says he still uses the observation and categorization skills he learned in his art history classes at USC Dornsife to
help him diagnose his patients today.
“There’s a lot of pattern recognition in art history and that goes for practicing medicine, too,” he says. “Physicians diagnose patients by putting their symptoms and complaints into categories and it’s a very similar mindset to how art historians study paintings.”
Huoh graduated as University Valedictorian in 2003. He credits his USC Dornsife education with making him the physician he is today; his psychobiology major taught him both how to understand people and how best to approach them, he says.
“Knowing why people think the way they do helped me as a physician to understand my patients, but also to understand my own biases and possible flaws in my reasoning.”
He found a developmental psychology course to be particularly useful in helping him to connect with his young patients.
“I’m treating kids from preterm infants to 18 year olds, so being able to understand what developmental phase children are in, being able to connect and understand their level of comprehension is vitally important. And that’s all stuff I learned at USC Dornsife. Plus, of course, the science — biology, chemistry, organic chemistry, physiology — all those classes I took there obviously laid the groundwork for my scientific ability to be a physician.”
Huoh pursued his medical education at the University of California, San Francisco (UCSF), where he met his future wife,
who now works as an anesthesiologist. The couple married during their residency training at UCSF, and they welcomed their first child while Huoh was serving as chief resident. He later completed his fellowship in pediatric otolaryngology at Stanford University.
For the last 10 years, Huoh has been a pediatric otolaryngologist at Children’s Hospital of Orange County (CHOC), specializing in head and neck tumors. As he puts it, “I do everything above the clavicles and up to the brain, so ear infections, hearing loss, sinusitis, tonsil conditions and pediatric thyroid surgery.”
Earlier this year, Huoh was honored with an invitation to give a grand rounds presentation — a prestigious educational lecture for doctors and medical students — at CHLA’s ear, nose and throat department. It was attended by Dr. Kenneth Geller, former chair of that department and former associate dean and director of the Prehealth Advisement Office at USC Dornsife.
“I had shadowed Dr. Geller when I was a freshman at USC Dornsife, and he was also one of the doctors who treated me when I was a child,” Huoh says. “So, it was really a full-circle moment returning to CHLA as a pediatric otolaryngologist and being invited to give a lecture to the department.”
As a surgeon operating on children with the same condition he had as a child, Huoh is in a unique position to be able to offer families reassurance drawn from his personal experience.
As a result, Huoh has formed particularly close relationships with some of his long-term patients.
Huoh says that what makes him happiest is successfully performing a difficult surgery with a good outcome for the child and their family.
“Being a physician is a hard job,” he says. “We deal with some pretty sick children at times, some very stressful situations sometimes, too, but overall, I feel so fortunate to be able to do this and be able to give back.
“Really, I’m living a dream.” D
1960s
William Altaffer (BA, history, ’67; MA, history, ’70), one of the world’s most traveled people, was granted emeritus membership to The Adventurers Club of Los Angeles.
1980s
Joseph Arleth (BA, economics, ’84) was appointed inaugural director of Examiner Education at the Federal Financial Institutions Examination Council.
Brian Cabrera (BA, political science, ’88; JD/MPA, ’90) was named general counsel and chief compliance officer of Quantum in San Jose, CA. Previously, he was an assistant United States attorney with the U.S. Department of Justice’s Criminal Division.
Kathleen Burns Campos (BA, history and international relations, ’83) was named to the 2024 Forbes ’ lists of
America’s Top Women Wealth Advisors and Top Women Wealth Advisors Best-In-State.
Bill Cernius (BA, economics, ’82) retired from his partnership with Latham & Watkins LLP after a 38-year career during which he became a nationally recognized expert in real estate trusts.
Arronda Douglas (BA, international relations, ’82), a principal at California’s Menifee Union School District, has been recognized by Marquis Who’s Who, a series of biographical volumes profiling individuals with noteworthy accomplishments.
Charles “Chris” Isleib (BA, English, ’85), director of public affairs at the U.S. World War I Centennial Commission, helped create the first national WWI memorial in Washington, D.C., honoring the Great War’s 4.7 million American veterans.
Neil Seigel (BA, mathematics, ’74; MA, mathematics, ’76) was awarded the National Medal of Technology and Innovation — the nation’s highest honor for technological achievements — by President Joe Biden at an October 2023 White House ceremony. Seigel led early efforts to bring digital technology to the U.S. military, work that drove technological advancements such as wireless internet and GPS-based vehicle tracking. He credits his mathematics education at USC Dornsife with laying the foundation for his career in innovation. “Learning the value of rigor and completeness, understanding how to tell if an argument is in fact rigorous (or not), and other types of general principles that we learn in mathematics has been fantastically helpful to everything that I have done in my career,” he says.
Paul Richardson (BA, political science, ’87; JD, ’90) was named senior executive vice president and chief human resources officer of The Walt Disney Co.
Karen Shanbrom (BA, sociology, ’82) is senior counsel at Erin Joyce Law, PC, in Pasadena, CA.
1990s
Millicent Borges Accardi (MPW, ’93) was a featured writer at Writer’s Week at the University of California, Riverside.
Mary Locke Cavallaro (BA, political science, ’90) celebrated 25 years of service with SAG-AFTRA, where she serves as the union’s chief broadcast officer.
Michael Patane (PhD, chemistry, ’91) was appointed to the board of directors of TFF Pharmaceuticals Inc.

Edoardo Ponti (BA, English, ’94; MFA, ’98) will direct the television adaptation of Laurie Fabiano’s best selling 2010 historical novel, Elizabeth Street.
Anthony Sparks (BFA, ’94; MA, American studies and ethnicity, ’09; PhD, American studies and ethnicity, ’12) is showrunner and executive producer of Choir on Disney+, a docuseries on the Detroit Youth Choir. He is also creating a scripted companion series.
2000s
Julie Albright (PhD, sociology, ’02) is the author of Left to Their Own Devices: How Digital Natives Are Reshaping the American Dream (Prometheus Books, 2023). Her book has inspired The Cost of Convenience, a film that explores the unintended consequences of digital connectivity and social media.
Jordan Bowne (BA, health and humanity and Italian, ’07) joined Boston law firm Casner & Edwards as an associate in the firm’s Trusts & Estates Group.
Martha Enciso (BA, sociology, ’03; ME, ’06; EdD, ’09), associate vice president for student affairs at California State University, Fullerton, won the National Association of Student Personnel Administrators’ 2023 Mena Valdez Award. She received the honor of Outstanding Senior Student Affairs Officer Award for providing advice, energy, leadership and guidance to the Latino community.

Gary Lai (BA, economics, ’02) won a Goody Business Book Award for Poverty and the Unequal Society in Hong Kong (Penguin Random House SEA, 2021).
Jennifer Malia (MA, English, ’02; PhD, English, ’09) was promoted to professor of English at Norfolk State University. She also wrote The Infinity Rainbow Club (Beaming Books, 2023, 2024), a children’s chapter book series.
Maura McGinnis Gibney (BA, sociology, ’03; MSW, ’06) was named executive director of California Advocates for Nursing Home Reform, a statewide nonprofit focused on improving access to quality long-term care options.
Rachel Middleman (MA, art history, ’06; PhD, art history, ’10) was promoted to professor and appointed chair of the Department of Art and Art History at California State University, Chico.
The new novel by Tea Obrecht (BA, creative writing and art
history, ’06), The Morningside (Random House), was named one of the Most Anticipated Books of 2024 by TIME.
Dana Smith (BA, psychology, ’09) was appointed to a permanent writing position at The New York Times
Jennifer Lynn Stoever (PhD, American studies and ethnicity, ’07) was awarded a National Endowment for the Humanities Fellowship in 2023 and The George A. and Eliza Gardner Howard Foundation Fellowship at Brown University.
Robert Suzuki (BA, philosophy, ’07) joined Pressed Juicery as senior vice president, people and culture. He is the USC Dornsife representative on the USC Board of Governors.
Tina Tran (BA, health and human sciences, ’09; MS, global medicine, ’09) earned a master of health science, physician assistant degree at Charles R. Drew University of Medicine and Science, Los Angeles, and became board certified.
2010s
Cale Bouchey (BA, philosophy, politics and law, ’14) joined Carmody MacDonald P.C. as an attorney in the firm’s business and transactional group.
Diane Marie Brown (MPW, ’11) published her debut novel, Black Candle Women (Graydon House, 2023), which was chosen as a Read with Jenna book club selection on NBC’s The Today Show The book will also be adapted for television by Universal TV and Jenna Bush Hager.
Jade Clemons (MA, economics, ’19), a former attorney and senior program manager at the Berggruen Institute, was hired to lead the Blue Sustainable Economy Alliance program, AltaSea’s business support program at the Port of Los Angeles.
Julia Cooperman (BA, English, ’12) is a writer on the Netflix series Jupiter’s Legacy, which follows the next generation of superheros.
Gabriela Cowperthwaite (MA, political science, ’99) directed a new film, I.S.S., which premiered at the 2023 Tribeca Film Festival and was theatrically released in Jan. 2024. Set on the International Space Station, the thriller portrays crew members fighting for station control after war breaks out between the United States and Russia. Cowperthwaite says her filmmaking career is shaped by her political science studies at USC Dornsife, which “gave me the idea that there are things out in the world that need our immediate attention.” Cowperthwaite is also known for her documentary work, including the 2013 film Blackfish, which received a BAFTA nomination for Best Documentary.

Samantha Coxe (BA, psychology, ’14), founder and CEO of electric flossing startup Flaus, won investment funding for her company while appearing on ABC’s Shark Tank. Advertised as “the world’s first electric flosser,” her company’s product was rated as one of the best inventions of 2023 by TIME. Coxe, a former corporate attorney, left her legal career in 2021 to launch Flaus.
Cate Hurley (BA, political science, ’17; BA, narrative studies, ’17) was promoted to principal deputy speechwriter for the U.S Office of Public Affairs at the U.S. Department of Energy.
Amanda Kennell (PhD, East Asian languages and cultures, ’17) joined the University of Notre Dame as an assistant professor of East Asian languages and cultures. She also published Alice in Japanese Wonderlands (University of Hawaii Press, 2023).
Jai-ayla Sutherland (BA, international relations, ’10) was unanimously elected by the Casper, WY, city council to fill the board’s empty Ward 1 seat.
Willis Tang (BS, human biology, ’22), spent the last year as an intramural research fellow at the National Institutes of Health in Bethesda, MD. There, he researched metabolic dysfunctionassociated steatotic liver disease — one of the most common causes of chronic liver disease worldwide. He also worked as a legislative ambassador with the American Cancer Society Cancer Action Network to advocate for equitable cancer policies at both the state and federal levels. Three of the high priority cancer bills he advocated for at the California State Capitol were signed into law by Gov. Gavin Newsom in Oct. 2023 — SB344, which optimizes the existing state cancer registry; SB421, which removes the sunset date for affordable oral chemotherapy; and SB496, which increases coverage for cancer biomarker testing. The Everyday Responder Project,
a nonprofit that Tang founded while at USC Dornsife, has now taught more than 3,000 students worldwide the skills of bystander first aid and has launched both a research branch and a health policy branch to advance access to quality first aid education for the lay population. The nonprofit also recently partnered with the California Department of Health Care Services to distribute cost-free naloxone (Narcan) to combat opioid overdoses across Los Angeles. Tang will start medical school at the University of California, San Francisco, in the fall.
“As I continue my professional journey, I hope to draw from my experiences in research, advocacy and entrepreneurship to become a physician who not only provides exemplary patient care, but also translates the insights gained from the clinic into equitable health care policies and novel medical innovations,” Tang says.

After a stint as an NIH research fellow in Maryland, nonprofit founder Willis Tang ’22 has returned to California to fulfill his dream of attending medical school.
Xueyou Wang (BA, English with an emphasis in creative writing, ’17) was named one of six 2023–24 Steinbeck Fellows at San Jose State University. Her work focuses on immigrant women’s experiences.
Eric Weintraub (BA, narrative studies, ’13) explores the expulsion of Jews from Spain in 1492 in his first novel, South of Sepharad (History Through Fiction, 2024).

Brandon Som (PhD, creative writing and literature, ’14) was awarded a Pulitzer Prize for his poetry collection Tripas (Georgia Review Books, 2023). The selection committee described Tripas as “a collection that deeply engages with the complexities of the poet’s dual Mexican and Chinese heritage, highlighting the dignity of his family’s working lives, creating community rather than conflict.” Som’s debut book of poetry, The Tribute Horse (Nightboat Books, 2014), won the prestigious Kate Tufts Discovery Award, given to poets who show great promise.

Renowned as a leader, researcher, mentor and collaborator, Jan Amend, divisional dean for the life sciences and professor of Earth sciences and biological sciences, died on Feb. 1. He was 59.
Amend brought his passion for probing the energetic interplay between life and its environment to USC Dornsife in 2011 and leaves behind an indelible legacy of scientific discovery and crossdisciplinary partnerships.
In support of NASA’s mission for life detection and habitability on Mars and as leader of a NASA Astrobiology Institute based at USC Dornsife, Amend was at the forefront of exploring life in extreme conditions, shedding light on the potential for life beyond Earth. He also sought to understand the origins and subsurface operations of life on our own planet.
In pursuit of answers to these questions, Amend assembled teams that brought together geochemists, geologists and microbiologists to combine laboratory
experimentation with fieldwork in extreme environments. This collaborative approach led them from the depths of a repurposed gold mine in South Dakota to the expansive biosphere beneath the ocean’s surface.
“His science was unique and constitutes a fundamental shift in our understanding of the thermodynamics of life in the environment,” said Frank Corsetti, chair of the Department of Earth Sciences. “Jan was also a tremendous advocate and facilitator for countless scientists as well as the field of geobiology. He facilitated the growth of geobiology across the globe.”
Among Amend’s many scientific achievements was the research he conducted that helped to reveal the many different ways that microbes could get energy depending on their environment — and how much they could obtain in each case. Working with Doug LaRowe, associate (research) professor of Earth sciences, Amend showed that microbes could survive on very low fluxes of energy, challenging existing notions of life’s limits.
In his capacity as USC Dornsife’s divisional dean for the life sciences, Amend was instrumental in recruiting eminent faculty, solidifying USC Dornsife’s position as a leading global center of marine microbiology and marine ecology. His leadership of the National Science Foundation Science and Technology Center for Dark Energy Biosphere Investigations (C-DEBI) was instrumental in fostering cutting-edge research into the deep subsurface biosphere.
At USC Dornsife, Amend was known not only for his impressive research, but also for his exceptional ability to forge connections, fostering cross-disciplinary collaborations within USC, across academia and with industry. His reputation as a generous and dedicated mentor was equally notable, marked by a sincere interest and investment in others and their ideas.
“Jan was a brilliant scientist and a generous and beloved mentor who was known for bringing out the best in teams of colleagues and students,” said USC Dornsife Dean Amber D. Miller. —S.B.

TRX SUSPENSION TRAINERS INVENTOR RANDY HETRICK’S CAREER PATH TO BECOMING A SUCCESSFUL ENTREPRENEUR HAS TAKEN SEVERAL UNEXPECTED TWISTS AND TURNS, FROM EARNING A HISTORY DEGREE AT USC DORNSIFE TO JOINING THE UNITED STATES NAVY SEALS TO BEING A LOBBYIST ON CAPITOL HILL. BY SUSAN BELL

Hetrick started wrestling in high school. Unwittingly, he was already laying down the ideal groundwork for acceptance into the U.S. Navy SEALs: “I discovered later that sports that do the best at SEAL selection are endurance sports with a high misery quotient and low crowd approval.”

Hetrick graduated from USC Dornsife in 1987 with a BA in history. “I pledged a fraternity, participated in everything and had an incredible mentor: USC President Emeritus John Hubbard, a WWII U.S. Navy bomber pilot and recipient of a Distinguished Flying Cross.” At USC, Hetrick learned teamwork by practicing another “hard and thankless” sport — rowing.
Following his parents’ divorce, Randy Hetrick grew up with his mother in the Southern California beach town of Corona del Mar. Money was tight, but her job as a flight attendant allowed them to travel for free to the United Kingdom, where they visited the castles that sparked Hetrick’s lifelong love of history.


Following a family tradition of military service that stretches back to the Civil War, Hetrick achieved his dream of joining the U.S. Navy SEALs in 1987. Of the notorious training known as “Hell Week” (attrition rate: 85%) he says, “You’ve got to be thick-skinned, lucky not to get hurt, and determined not to let your mind fail you. That was my specialty and still is as an entrepreneur. It’s a propensity for biting down on your mouthpiece and grinding through.”

The idea for Hetrick’s TRX Bands was born of necessity. Deployed without training equipment on a counter-piracy operation in Southeast Asia. Hetrick resorted to using his jujutsu belt. “I tied a knot in it, threw it over a door, leaned back against gravity and lifted my body. The possibilities opened up like a flower.”


After earning a master’s degree in national security affairs at the Naval Postgraduate School in 1994, Hetrick was selected to join an elite counterterror unit. From 1997 to 1999, he served as the principal lobbyist on Capitol Hill for U.S. Special Operations Command, representing a portfolio of more than $1.3 billion in active programs. Returning to active service, he finished his 14-year military career as squadron commander.

TRX Training was launched from Hetrick’s garage in 2004, one year after finishing his MBA at Stanford University. It has grown from a bootstrap start-up to a leading, global physical training brand. He launched his second start-up, Outfit Training, a technology-enabled outdoor mobile fitness franchise, in 2021.

BY AZKA SATTAR CREATIVE WRITING CONTEST
Congratulations to the winner of the third USC Dornsife Magazine Creative Writing Contest — Azka Sattar. A junior majoring in psychology, her winning entry, “Persist,” was the unanimous choice of the contest’s judges: Dana Johnson, chair and professor of English and director of the USC Dornsife PhD in Creative Writing & Literature program; David Ulin, professor of the practice of English and editorin-chief of USC Dornsife’s online literary magazine Air/Light ; and Susan Bell, editor-in-chief of USC Dornsife Magazine.
The contest, open to USC Dornsife alumni and students, attracted entries across a diverse range of majors. The brief was to write a maximum of 500 words inspired by the theme of this issue, “Health and Well-being,” in any of the following genres: fiction, poetry, memoir or essay.
The judges were impressed by the high quality of work submitted and would like to thank everyone who participated. To read the second- and third-place winning entries visit: dornsife.usc.edu/ runners-up-SS 24
There was a clay cup in my family, handed down from the generations. When it was my turn, I looked after it with naive ambition. It was a beautiful cup, crimson and flawless, showing no signs of its age. Blue designs streaked across it, like lines on a map. I showed this cup to everyone I met. I didn’t realize that precious things shouldn’t be accessible to the world.
When I was 16, for the first time, a boy asked to drink water from my cup. I gave it to him, so excited for him to notice the details I see every day. I wanted to hear him say that even ordinary water tasted magical from this cup. I should have thought twice, but I was too young to know any better. He said it was an accident, the cup just slipped from his grip, and he didn’t mean it. If I think back now, I will swear he dropped it with purpose. What I do know for sure, is that he made no move to catch it as it fell. I sank to my knees and cried over the broken pieces of my cup, while he offered his superficial excuses, before finally, leaving me alone.
It took me a week to find the pieces of the cup from where they had scattered. I laid them all out on the floor and looked at them through tearful eyes. I was so sure that I was missing a part. The boy must have stepped on it on his way out. I’ll never find it again. My broken cup will always be missing a section. No one will ever drink out of this cup again.
A year later I was so thirsty. I needed water from my cup, and I decided I was going to make that happen, no matter what. I sat down with the pieces and slowly, carefully, with all the love I could muster, I joined the pieces together. The lacquer I used was mixed with gold. It took me almost a year to fully heal my cup. And when I was done, it was beautiful. I could see where it had cracked, but the gold lines just made it more valuable.
Now I am certain, there is no cup like this in the whole world.

Azka Sattar grew up in Pakistan and started writing stories as a child to express herself.
Recently, her writing has been inspired by music, particularly by songs in her native language, Urdu.
“They are mostly rap songs that, for me, convey feelings English songs don’t fully capture,” she says. “When I write, I try to express those emotions in a story.
“I hope ‘Persist’ conveys that the experiences that we go through, even if they are difficult and heart breaking, can still be healed into beauty.”
After graduating next year, Sattar aims to earn a PhD and put her psychology degree to good use by working as a clinical therapist for adolescents. She also plans to continue writing. “It’s always been my dream to publish a few books — a passion to pursue alongside my prospective career as a therapist.”

“I hope ‘Persist’ conveys that the experiences that we go through, even if they are difficult and heart breaking, can still be healed into beauty.”
“In five brief paragraphs, Azka Sattar gets to the heart of the matter, evoking love and loss and reconciliation, finding strength and restoration in the simplest of gestures, the reconstruction of a broken cup.”
DAVID ULIN PROFESSOR OF THE PRACTICE OF ENGLISH
GET INSPIRED BY OUR NEXT THEME: CALIFORNIA
As an alum or student of USC Dornsife, you are invited to enter the USC Dornsife Magazine Creative Writing Contest. The winner will have their work published in USC Dornsife Magazine, which has won more than 45 awards for excellence and is distributed to 70,000 alumni, faculty, staff, parents and friends of USC Dornsife. ENTER BY SEPT. 15. Scan below for details.


About 10% of the world’s population gets migraines — including some 47 million Americans. These severe headaches, often accompanied by nausea and light sensitivity, can last for days. Some treatments exist, but they don’t work for every patient and research into better medications traditionally hasn’t been well funded.
HYPOTHESIS
David McKemy, professor of biological sciences, thinks one solution might lie in a protein called TRPM8. He recently discovered that the protein, which is crucial to cold detection, also plays a role in headaches. Could inhibiting TRPM8, thereby interfering with its function, stave off migraines?
ANALYSIS
McKemy’s research reveals that TRPM8 could be a promising target for new drugs aimed at treating migraines. He is now advancing his research on a potential cure, with a forthcoming study looking at the genetic factors that contribute to migraine susceptibility.


McKemy conducted experiments where he administered headacheinducing agents — nitroglycerin and a peptide known as CGRP — to mice genetically engineered without the TRPM8 protein. Remarkably, these mice showed no signs of migraine-like pain. Additionally, McKemy discovered that inhibiting the function of this protein pharmacologically in normal mice prevented the pain associated with headaches.
Migraine relief could be closer than we think, thanks to McKemy and to Arnold and Roberta “Bobbi” Mahler ’66. The Mahlers recently donated $2 million to USC Dornsife to accelerate migraine research like that being done by McKemy.
The gift was made in honor of the couple’s daughter, a life-long migraine patient.
“We want help for migraine sufferers sooner, better, faster,” says Bobbi Mahler.

ON TOP OF THE WORLD
Students trek the Los Leones Trail in the Santa Monica Mountains above Malibu, California, on a hike led by Andrew De Silva, associate professor (teaching) of writing. The April outing was organized by Peaks and Professors, a student organization that unites USC professors and students for adventures in the California wilderness, with activities ranging from day hikes to multiday backpacking trips. The goal? To encourage students and professors to form positive relationships by engaging in intellectually curious conversations in beautiful environments. Did they spot any mountain lions? No, but they did see a lot of stunning California scenery, including this spectacular ocean view.
University of Southern California SCT-2400
Los Angeles, California 90089
CHANGE SERVICE REQUESTED

Expert insights for a longer, happier, healthier life.
Page 20
Born with a giant tumor, he beat the odds to become a pediatric surgeon. Meet Kevin Huoh ’03.
Page 44
Developing effective pain medication — without the addiction risk.
Page 40
Explore the wacky world of quack medicine.
Page 12
Is Technology Making Us More or Less Healthy? Two experts debate the issue.
Page 16